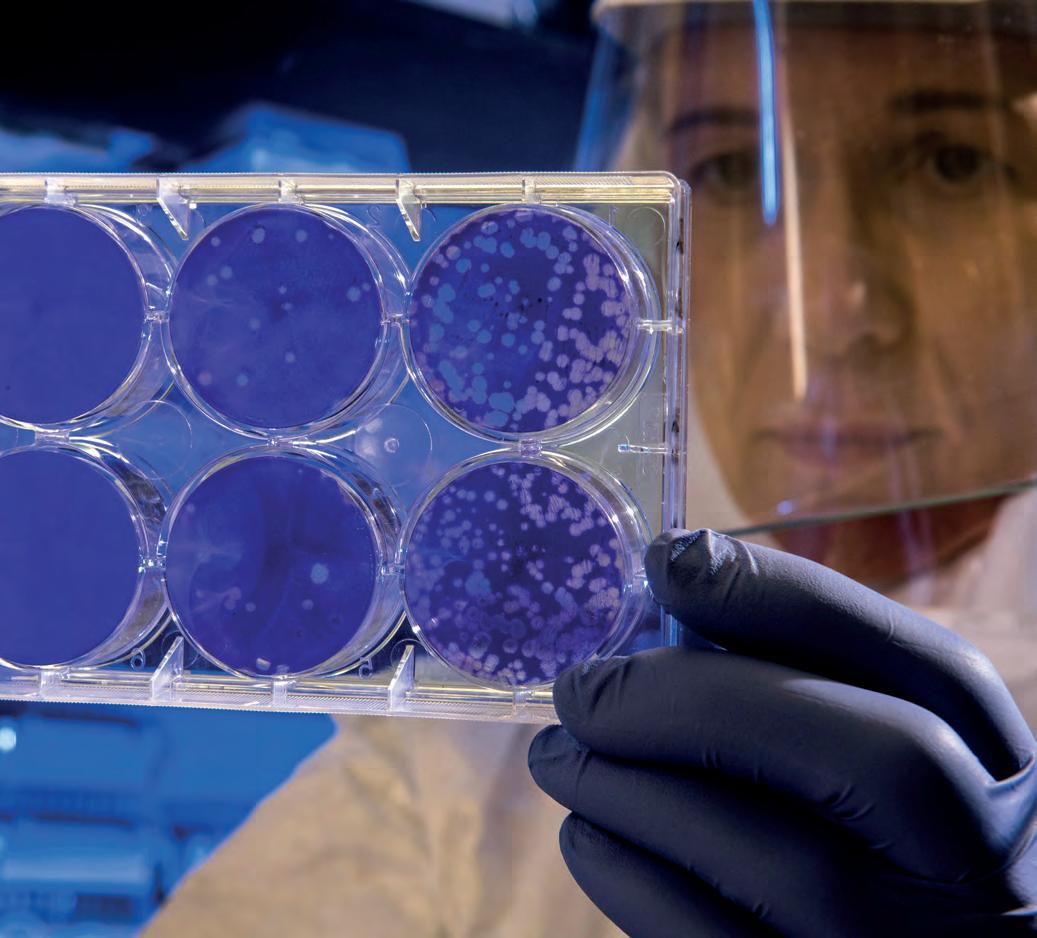

![]()







Minister for Nature, Heritage and Electoral Reform and Green Party TD for Carlow Kilkenny, Malcolm Noonan, has announced that, thanks to a new funding initiative, Kilkenny County Council will recruit a county archivist in 2025. Almost €1m in funding will be made available in 2025 for the recruitment of heri-
tage professionals across the country, working within local authorities to strengthen the protection of heritage assets.
Making the announcement at Butler House and Gardens in Kilkenny, Minister Noonan said:
“It has been my long-held ambition that every local authority in Ireland should have
Two Transition Year students from Kilkenny are among 14 TY students from across the South East region celebrating this after taking part in TY Media Week at Beat 102 103.
The TY Media Week is a unique, creative, and innovative programme, which allows the broadcast media sector to engage with TY students in a way that is fun, creative, and engaging.
The programme enables participants to understand how the media works, how content is created, and how the information that is broadcast is verified.
The two students from Kilkenny are Ciara Ryan from Coláiste Abhainn Rí and Michael Maher from St. Kieran’s College.
Our photo shows winner Michael Maher with Jade Maher.
a full complement of heritage professionals on staff, and in particular I’ve been anxious to see a county archivist for Kilkenny. I’m delighted to announce that the funding I’m making available for the recruitment of additional heritage professionals to local authorities in 2025 will allow Kilkenny County Council
to have a county archivist in place from next year.
“This is part of a wider recruitment programme that will see more heritage professionals working in all our local authorities, including archaeologists, archivists and architectural conservation officers - hugely important posts creating interdisciplinary teams
that can work together on a wide range of projects and draw down heritage funding from various sources,” he said.
“Having a county archivist for Kilkenny is essential because we hold records here that are among the oldest and most important in Britain or Ireland. It is vital that every County Council has in place a

WeCan, a Kilkenny CluneTech initiative, has been awarded Best Deposit Return Initiative at the 2024 Pakman Awards, held recently at The Shelbourne Hotel, Dublin. Launched in June 2024, WeCan has achieved its first major recognition, marking a significant milestone in its commitment to inclusion and sustainability.
The Pakman Awards are Ireland’s premier environmental
awards, recognising excellence in recycling and waste management among businesses, community groups, and individuals. Celebrating its 10th anniversary this year, the awards shine a spotlight on organisations demonstrating outstanding sustainability efforts.
WeCan blends social inclusion with environmental responsibility by providing adults with intellectual dis-
abilities meaningful employment that is in line with their capabilities. WeCan also offers businesses a sustainable and practical solution for returning their cans and bottles that they can leverage to benefit their own operations, ESG, and CSR objectives.
Terry Clune, CEO and Founder of Kilkenny-based CluneTech, said: “Winning the Best Deposit Return Initiative at the 2024 Pakman

Awards is a tremendous honour and a testament to the meaningful impact of WeCan. Since its launch, WeCan has not only promoted sustainability but has also empowered individuals with intellectual disabilities to secure meaningful employment.
“I want to extend a special thanks to Johnny McCarthy, his son Adam, and the wider team for their contributions in bringing this idea to life.”

The initiative collaborates closely with the Work4Life Employment Support team from SOS Kilkenny CLG, a not-for-profit organisation that supports individuals with intellectual disabilities and autism in Kilkenny. This collaboration aids in workplace integration and reflects CluneTech’s dedication to positively impacting both the community and the environment.

county archivist to collect, collate and conserve important historical documents.
“So this is a really wonderful announcement and I’m delighted as Minister for Heritage to have been able to work with the Heritage Council over the past number of years to deliver this really important post for our city and county.”
Big changes for banks in Callan and Hight St
AIB has begun a strategic investment programme in its branch network, investing €40 million by the end of 2025 in a range of upgrades to branches and ATMs, including Kilkenny. This investment will reduce operational carbon emissions by a further 10% and, with certified renewable electricity from two solar farms in Wexford, will help support AIB’s strategy to be net zero across Scope 1 and 2 emissions by 2030. In Kilkenny, the Callan and High Street, Kilkenny branches will have interior and exterior improvements made.
Kilkenny Regional Retail Director, Gaye O’Connell said: “AIB has a longstanding commitment to communities across Kilkenny, and we’re proud to continue with improvements made to our Callan and High Street, Kilkenny branches.”
Ryan O’Meara endorsed for general election
Cllr Ryan O’Meara has secured the endorsement of Cllrs Michael Delaney, Pat Fitzpatrick and Michael McCarthy in his bid to become the Fianna Fáil candidate in North Tipperary / Northwest Kilkenny for the upcoming General Election. Full story, Page 6

The Competition and Consumer Protection Commission (CCPC), Ireland’s statutory body for enforcing consumer protection and competition law, marked its 10 year anniversary with an event held at Dublin’s Gresham Hotel.
The occasion was led by CCPC Chair Brian McHugh and attended by Emer Higgins TD, Minister of State at the Department of Enterprise, Trade and Employment.
Reflecting on a decade of safeguarding consumer rights and promoting fair competition, the event included a series of panel discussions on past achievements and future challenges facing Ireland and its economy. The CCPC was established in October 2014 following the merger of the National Consumer Agency and The Competition Authority.
In his keynote speech, Chairperson Brian McHugh emphasised the need for more substantial penalties for companies that breach the law:
“This week the Data Protection Commission fined a social media company €310 million, but earlier this year when Tesco pled guilty to failing to display prices correctly, the outcome was a €1,000 donation to charity. The current consumer protection regime is no deterrent;

consumers deserve better.
“We want the Government to give us the power to impose large fines for serious offences – a percentage of that business’s turnover.”
He further highlighted the persistent issue of consumer protection law violations, which inflict significant damage on Irish consumers and businesses:
“Our inspectors find businesses following the law, showing that it’s not complicated to do so,” he said.
“To send a clear message to all businesses on the importance of consumer protection law, the punishment should fit the crime. Fines need to be big enough to stop even the largest businesses from breaking the law.”
Minister Emer Higgins praised the CCPC’s decade-long contribution, stating: “Over the last decade the CCPC has made a significant impact across competition, consumer protection and product safety.
“ In recognition of its important role in the continued strength of the Irish economy, the Taoiseach’s Competitiveness Summit on September 2 called upon the CCPC to identify and remove barriers to competition in domestic markets, thereby reducing costs for business and consumers.”


The Social Democrats have revealed ambitious plans for the delivery of tens of thousands of affordable homes over a five-year period.
Details of the fully costed proposals are outlined in the party’s new policy document, ‘Homes Within Reach – Our Plan for Affordable Housing’.
The policy sets out how, in
government, the Social Democrats would deliver 50,000 affordable purchase homes and 25,000 affordable rental homes over five years. This will be in addition to social and private sector delivery.
Under the plan, affordable purchase homes will be sold for less than €260,000 in Kilkenny and Kilkenny, with buyers owning 100% of their
Stroke patients in Kilkenny recently joined a series of free talks designed to support their recovery.
Three webinars organised by the national stroke and heart charity, the Irish Heart Foundation, will focus on fatigue, trauma and personal experience.
The first of the online talks took place on World Stroke Day on Tuesday, October 29 last, where stroke survivor Dermot Berry shared his personal journey on recovery following a spinal stroke in June 2018.
After paralysis Dermot regained his ability to walk and is now a member of the Irish Wheelchair basketball team.
On Wednesday October 30, Gary Broderick, from the Learning Curve Institute, delved into the practical aspects of implementing Trauma Informed Practice and its significance on recovery.
Gary is CEO of SAOL Project and is a trainer in motivational interviewing. He teaches on the master’s in social work courses in TCD, UCD and Maynooth on addiction and trauma informed practice
Ciara Breen is an Occupational Therapist Manager in Galway University Hospital and the National HSCP Lead for the Clinical Programme for Stroke. She spoke Thursday, October 31 on coping with fatigue from a heart condition or stroke.
This is aimed at people who are affected by fatigue after a stroke, cardiac arrest, or when living with a heart condition.
Ciara revealed how to rec-
ognise heart or stroke-related fatigue and share practical tips and strategies to help manage this.
The webinars were of interest to all patient supports services available through the Irish Heart Foundation, such as the Stroke Connect Service for newly discharged stroke patients, in-person stroke support meetings across the country, a Young Stroke Support Network, music and art therapy, weekly online exercise sessions and a Life After Stroke private Facebook group.
The Irish Heart Foundation is highlighting the benefits of physical activity for stroke.
“Being active is one of the best things you can do for your health, especially in the aftermath of a stroke,” said Helen Gaynor, Irish Heart Foundation’s Head of Community Support Services.
“Research shows positive outcomes for stroke survivors who exercise, which include improved physical function, such as mobility, walking and balance, and improved mental function.
“Repetition is key and helps you adapt to everyday living –learning fine and gross motor skills when exercising can help in daily chores, such as knowing which arm to use for picking up groceries in the shop.”
The Irish Heart Foundation offers exercise through a number of support services.
* To learn more about Irish Heart Foundation support services, visit: https://irishheart.ie
Two Kilkenny farmers are among the winners of Farming for Nature Ambassador Awards 2024. The are Bryan and Gail Daniels, dairy farmers. The Farming For Nature project, founded in 2018, seeks to acknowledge and support farmers who farm, or wish to farm, in a way that will improve the natural health of the countryside. The network has now grown to having 102 Ambassadors from all over the country. This organisation received 21 nominations from farming and conservation organisations around the country. However, only 12 could be chosen to win this year’s awards.
home and the land on which it is built. These costings will regularly be revised on the basis of building cost inflation.
Speaking at the launch, Cian O’Callaghan TD, the party’s housing spokesperson, said:
“It should not be as hard as it is now to get a home of your own, whether you want to
rent or buy. Everyone should have access to a safe, secure, high-quality home that they can afford.
“Ireland has the land and the money to achieve what we have proposed in our affordable housing plan. What we need is a government that is willing and capable to get the job done.”
Patricia Stephenson, Social
Democrat candidate for Carlow-Kilkenny said: “We strongly believe that access to affordable housing is fundamental for the prosperity of people in Ireland. The housing crisis is impacting everything, rising mortgage payments and rents up 54% in Kilkenny and 53% in Carlow since Covid, means that working families are
struggling with all the additional cost of living increases even more.
“We need truly affordable homes for both purchase and rent in Carlow and Kilkenny and our plan affordable housing plan will deliver that. We have the money and the land to do it, we just need a government which is committed to it.”

He’s our local champion!
From left , Stephen Healy, PV Gen (sponsor), Niels Erik Haahr (Judge), Steve McLoughlin (handler), Padraic Murphy (Owner) and Andrea Murphy, Ballagh, Kilmanagh, Co. Kilkenny.
Photograph: Mathias Penn
Cllr Ryan O’Meara has secured the endorsement of Cllrs Michael Delaney, Pat Fitzpatrick and Michael McCarthy in his bid to become the Fianna Fáil candidate in North Tipperary / Northwest Kilkenny for the upcoming General Election. Speaking after receiving the support of all three County Councillors who represent
the Municipal District of Castlecomer, which is being partially incorporated into the new North Tipperary / Northwest Kilkenny constituency in this year’s General Election, Cllr Ryan O’Meara said: “I would like to thank Cllrs Michael Delaney, Pat Fitzpatrick and Michael McCarthy for their endorsement and support in advance of
the Fianna Fáil selection process to stand for the Party in this area.
“I have worked closely with Deputy Jackie Cahill in the Northwest Kilkenny area since the announcement of the new constituency boundaries last year. I am very grateful to Cllrs Delany, Fitzpatrick and McCarthy for their support and advice to
date,” he said.
“I have publicly committed to working hard on behalf of the people of Northwest Kilkenny if elected to the Dáil later this year, and I greatly appreciate the endorsement of my Fianna Fáil colleagues in Kilkenny County Council in my bid to secure the nomination to stand for Fianna Fáil.”
With clocks gone back seeing the return of nights-in, sat in front of the telly, a new study from McDonald’s Ireland reveals a growing sense of nostalgia for the golden age of family TV.
A new poll of 2,000 Irish
adults has revealed of those based in Leinster, 77% feel nostalgic for the classic family TV shows of the 90s, with 89% claiming they loved Saturday nights in front of the TV when they were younger.
The study highlights Ire-
land’s favourite family TV shows, both past and present, with I’m A Celebrity… Get Me Out Of Here!, Britain’s Got Talent and X Factor topping the list in Leinster.
The study also reveals five in 10 often have their dinner
in front of the telly at the weekend watching some classic family entertainment. And 40% who have a ‘family night in’ on Saturdays often get their evening meal ordered in to minimise cooking while enjoying the TV.


In the weeks, and now days, leading up to November 5, Kamala Harris has been keeping her words to familiar themes – reducing the costs of medicines, housing and food. “I come from the middle class, and I will never forget where I come from,” she has repeatedly said.
Trump would slash the Affordable Care Act and roll back the $35 cap on insulin, the Democratic nominee warns and has reaffirmed her support for abortion rights, saying: “Donald Trump still refuses to acknowledge the pain and suffering he has caused … women are being denied care during miscarriages.”
While some commentators have suggested that the Harris campaign has been losing support among Black male voters, from what I can see such an assertion doesn’t carry much weight with Democrats on the road
with Kamala Harris. She has been poking serious fun at Trump by questioning his fitness and dismissing him as “weak and tired”, and alleging his team cited “exhaustion” when he was bowing out of some media appearances. Not without some truth, perhaps. Trump’s behaviour, meanwhile, has, indeed, become increasingly erratic that people no longer take the Republican leader seriously but do argue that just because he’s seemingly a sandwich short of the picnic doesn’t mean his presidency wouldn’t be dangerous.
Trump says he wants a presidential victory on November 5 to be so overwhelming that the results are “too big to rig”. The Republican, who still refuses to accept that he lost the 2020 election to Democrat Joe Biden, told supporters in the state of Georgia: “We want a
landslide. We can’t let anything happen.”
Whatever the margins, Republicans and Democrats are preparing for a potentially lengthy battle over the results once they come in. Dozens of lawsuits, that could set the stage for challenges after the votes are counted, are already playing out in courts across North America – with most being filed by Republicans and their allies.
Elsewhere, there’s little incentive – despite the horrific mass shootings – for Republicans to change course on their stance of their right to bear arms, particularly in the ‘swing states’ where gun ownership remains high and the GOP is riding a wave of momentum.
Even Democrats in Arizona, Georgia, Nevada and New Hampshire have shied away from articulating specific policy demands, instead of-
fering vague suggestions that “something should be done” to protect children.
In the final analysis, it will be all down to the outcomes in the aforementioned swing states – that crazy electoral college system that allows just a couple of handfuls of
“She has been poking serious fun at Trump by questioning his fitness ...
voters have the final say. Of the current 538 such electors, a simple majority of 270 is required to elect the president and the vice-president.
If no candidate has that majority, then a contingent election is held by the House of Representatives to elect the president and by the Senate to elect the vicepresident.
Trump and his followers might not be as confident about victory as they’re projecting, though that’s undeniably their public posture, while Harris is playing it cool, holding to her early notion that she’s the underdog. In fact, few inside the Harris camp or among her top allies believe she’s a sure bet. Nervous Democrats are increasingly nervous, and the switch in momentum to Trump in recent weeks — based in part by slight shifts in polls — has intensified their fears.
It’s difficult to conclude that the attitudes of each party about what has long been a coin-toss election aren’t having an impact. In the long run, relying on what the candidates or their campaigns are saying about their standing in the race isn’t always a good indicator of where things stand – as we know here from experience.
For the anti-Trump brigade, it’s been another tough election cycle of Democratic officials and operatives sounding the alarm about a crucial voting bloc or hitting the panic button over their standing in a battleground state. America’s politics have always been complex and complicated. However such, at the end of the day it will be down to those handful of votes. Were I a betting man whom might I put my few bob on?




On Saturday the 19th of October, Castlecomer Credit Union was represented at the annual All-Ireland Credit Union Awards. There were a number of categories in the areas of community involvement, sustainability, volunteerism, leadership, mental health and social dividend to name but a few. Castlecomer did quite well with their CEO Gerry Reynolds collecting the Distinguished Leader of the Year Award. Castlecomer Credit Union polled well in the Credit Union Members Choice Award, but unfortunately not quite enough to win it. For a small Credit Union this is a great achievement and congratulations to the board of directors, the staff, the volunteers and the members on this achievement.

Illann Power, the 32-year-old Carlow entrepreneur, has been charged with 84 new offences following an extensive Revenue Commissioners investigation.
Power, who was already facing three charges from the Corporate Enforcement Authority (CEA) for knowingly or recklessly furnishing false company returns, was arrested outside of the Criminal Courts of Justice, Dublin, following a
hearing on October 1 and was charged with the new Revenue offences.
Mr Power told the Sunday Independent that the new charges were put to him "by appointment” and were heard in an evening sitting of the District Court.
The prosecution is seeking to have the CEA charges, which were first made in 2022, and the new Revenue charges all heard together at Circuit Court level.
Mr Power said he would await the serving of the book of evidence before deciding on his plea to the Revenue charges. He has pleaded not guilty to the CEA charges.
The Carlow entrepreneur, who was involved in running a drinks business before moving to America, has been in a longrunning legal battle in Florida with the Revenue Commissioners where it has opposed his attempts to have his debts
discharged in a bankruptcy in the south-east US state.
Mr Power said that the Revenue Commissioners had also taken a new High Court action against him here to seek a summary judgment for €1.2m in income tax and another €750,000 in penalties.
He said he planned to challenge the decision to have the CEA charges heard in the Circuit Court. Power said he believed a lot of the Revenue
charges were "barred by statute of limitations”.
Among the 84 new criminal charges Power is facing is a charge of forgery. He is alleged to have electronically amended a High Court order on dates between December 1 and December 14 in 2022, with the intention that it be used to "induce another person to accept it as a genuine” to the prejudice of that person or any other person.
That offence is alleged to be contrary to the Criminal Justice (Theft and Fraud Offences) Act 2001.
He is also accused of electronically altering a High Court order in a way that had a tendency to "pervert the course of public justice” by adding information that was not granted by the court.
The remaining 82 charges relate to alleged breaches of tax law.
The Government has said it will not support laws it feels interfere with the commercial beef market, reaffirming its longrunning positing on beef-price disputes.
It comes after a debate in the Dáil on a Bill developed by Aontú Leader Peadar Tóibín, which aimed to ban the belowcost-of-sale beef.
The legislation would prevent the purchase of cattle from a farmer at a price below the minimum amount for the time prescribed by ministerial order. That ministerial order would be based upon the price decided by Teagasc.
However, in a debate on the Bill , the Government said it could not support the legislation.
Outlining its position, Minister of State at the Department of Transport James Lawless said the proposed legislation would seek to involve the Minister in what were currently private commercial matters and said it contained measures that were likely to have unintended consequences and would be detrimental to the sector.
He pointed out that Ireland was almost 700% self-sufficient in beef production at present and Irish beef prices were influenced, not just by demand and supply dynamics in the domestic market, but also by conditions in the main export destinations, primarily the UK and EU.
"Legislating as proposed in this Bill would serve to distort
the market and reduce Ireland's overall competitiveness in the sector, as it fails to account for the degree of dependence on international trade and the potential impact of product substitution,” he said.
He claimed the measures proposed could paradoxically have the effect of reducing sales from Irish farms, resulting in industry contraction and the gradual erosion of demand from the processing sector.
He also said the proposed legislation was unlikely to meet the EU legal test for a justified and proportionate restriction on trade and would serve to distort the market and reduce Ireland's overall competitiveness in the sector.
Mr Tóibín conceded that "the Bill is not perfect”, but said it was "a monumental step forward” and claimed Fianna Fáil supported the laws in opposition.
The Government, he said, was missing the point that the market was already distorted.
"The situation is the Government is presiding over an oligopoly whereby a small number of factories and supermarkets have enormous buyer power. They can do what they want.
"They can squeeze those farmers down to the last cent if they so wish. There is nothing to hold them back. There are no protections there. They do it on a regular basis. As a result, we see farmers having to strike and protest outside of factories,” he said.
A Japanese village struggling with low population has created life-sized dolls to mimic the feeling of bustling society. Residents of Ichinono crafted the stuffed dolls, Hisayo Yamazaki, an 88-year-old widow, said: "We’re probably outnumbered by puppets" amid the village's silence. Ichiro Sawayama, head of the village's governing body, warned that, without changes, extinction awaited them.
The Japanese hamlet has less than 60 residents.

Fabian Gaspari, who grew up in Ossory, recently set about rejuvenating an area that had been far too long neglected and "not seen as the major route it is through the heart of our
city". He said: "Grafitti, broken glass, dumping etc, I wanted it to be a space for everyone to be proud of and feel safe walking though especially the school children," he said.
Plans included a bin, signage, bicycle lane, CCTV and of course a mural.
Mr Gaspari said: "Thanks to Cllr Maria Dollard who instantly responded to me
about my idea and got it in motion the mural is going ahead through a collaboration of Ossory Youth, Keep Kilkenny Beautiful, and Kilkenny County Council. Very much appreciated"
Ireland South MEP Cynthia Ní Mhurchú has welcomed the scrapping of the Short Term Letting Bill saying that while it is well intentioned, it would have damaged the tourism market in rural Ireland, and in particular in the South East According to Ms Ní Mhurchú, there are flaws in the bill that mean that while it is certain to do damage to rural tourism in Ireland, there is no guarantee that it will bring about the intended release of properties back into the long term rental market,
“There are absolutely no guarantees that those short term rental properties that would have been forced out of the tourism rental market will rent out their properties on the long term rental market. Many of the the tourism providers that I have met with say that their properties are not suitable for the long term market or that they have no interest in letting out their properties on a year round basis.
"We have no evidence that points to the fact that this bill would have brought 10,000 properties back into the
long term rental market. We do know that taking 10,000 short term lets out of our tourism market overnight is sure to damage our rural tourism industry.”
Ms Ní Mhurchú criticised the fact that this Bill had been left hanging over our tourist accommodation providers for almost 3 years creating a sense of panic and uncertainty in the market,
“Tourism operators are owed an apology. This bill has caused uncertainty and led some tourism providers not to accept long term bookings. That caused great
stress and anxiety to tourism providers who typically take bookings up to 12 months in advance. I would like Catherine Martin to apologise to them for that stress.”
Ms Ní Mhurchú says the short term lettings Bill is well intentioned and may be more suitable to Irish cities but that its impact on rural Ireland’s tourism market had not been taken into consideration. Ní Mhurchú says that tourism providers are already under significant pressure given the cost of living crisis, higher VAT rate and poor summer weather."


My word association with the word pouch used to be Kangaroo, a nice safe pocket for Baby Roo to keep him warm while his mum hops about the place. That was until Norma Foley decided that secondary school pupils should have nice safe pouches for their smartphones to stop teenagers accessing them during time in school. What prompted the Minister for Education to lash out €9 million of taxpayers’ money on €20 pouches? As teenagers head back to their classrooms after the Halloween break, it’s a good question. It might be fashionable concern prompted by Jonathan Haidt’s bestselling book The Anxious Generation. The social psychologist from New York University quotes data showing soaring rates of anxiety, depression and selfharm among teenagers and he blames social media and smartphones. Other studies
link smartphone overuse with social harm to teens too. It might have been a desire to buy parental votes in the October 1 Budget, where the Coalition flung money about like confetti. But the effect of the largesse has voters worrying about profligacy and failure to invest in significant change rather than increasing the Government’s popularity.
Minister Foley says she wants to make school smartphone-free for the sake of children’s mental health. “We want a uniform approach where there will be no access to mobile phones throughout the school day. So we have provided €9m. for that, for the purchase of things like pouches or whatever types of solutions that might be identified by the school.” (Oddly, a search on line for pouches revealed most models cost much less than €20.)
And her decision wasn’t a response to something that
teachers asked for – ASTI wasn’t even consulted about the move and the association is critical of the Budget for failing to provide resources for serious issues facing schools. “The measure regarding student pouches in schools for mobile phones shows the extent to which meaningful engagement regarding the big issues in education is being avoided,” an ASTI spokesperson told me. “The recruitment and retention crisis deteriorates every week in many of our schools and the scars of years of underinvestment. The OECD Education At A Glance 2024 report ranked Ireland in last place out of 34 countries for investment in education as a proportion of GDP.” It isn’t a decision which is going to cure any harm caused to teens by smartphones either, as pouches are just a sticking plaster over the symptoms.
Smartphones per se are
Discover the spells cast on society during the Kilkenny Witch Trials
As part of Kilkenny’s Toil & Trouble, a festival of events commemorating the 700th anniversary of the witch trials, Kilkenny County Council Library Service are delighted to present this activity book “Kilkenny’s Toil & Trouble Schools’ Activities Packs” which was developed by staff working in the Local Studies Department and funded by Kilkenny County Council. The activity book, designed for 5 to12 year olds, will be delivered to over 13,000 primary school children around the
County and includes lots of information, activity sheets, crosswords, word searches, witch wreath craft, fact sheets, puzzles and lots of other fun activities suitable for primary school children.
“We invite you to explore this pivotal event in Kilkenny’s history by delving into the pages of this book, we encourage children to explore their local history and step back in time to 1324 to uncover the chilling tale of Ireland’s first witchcraft trial and learn about the powerful and wealthy Alice
Kyteler, accused of witchcraft and heresy by the Bishop of Ossory, Richard Ledrede and also explore the tragic fate of Petronella de Meath, the first person in Ireland to be executed for witchcraft” says Alicia Dunphy, Library Staff Officer, Local Studies Department.
The Kilkenny’s Toil & Trouble Schools’ Activities Packs will be distributed to all primary schools in Kilkenny in time for Halloween and there will be copies available in Library branches around the County while stocks last.

not the problem – it’s the access they give to social media, porn, disinformation and the way they are used. Smartphones are part of our lives now; teens need to learn
“He blames social media and smartphones...
how to use them responsibly and isn’t it up to parents and teachers to facilitate that lesson? And isn’t it up to Government and all of us to insist that that the big social media companies crack down on undesirable content?
Pouching phones seem a bit like a spaghetti western, where cowboys leave their guns at the door of the saloon because they can’t be trusted not to start a shoot up.
Taking away phones sends a message about a lack of trust and it’s an imposed decision which avoids the issue of discipline.
If parents are concerned about the potential harm to young minds why give teenagers smartphones in the first place, why not give them ‘dumbphones’ instead which don’t connect with the internet?
Parent /child agreements about rationing screen time and education about avoidance of cyber bullying and
harmful content make sense. Most schools already have measures in place to deal with smartphone usage, as part of policies which are agreed the boards of management and with the school community. Policy around cell phones in secondary schools varies according to the needs of each school community, from no use during school hours to limited use for education purposes.
The details of the pouch measure, due to come into effect next year haven’t been released yet. Given the general reaction to the €9m. spend in contrast to crying needs homeless children, children in care and children in need of medical or psychological treatment. It seems it will be added to the list of Government follies, together with the infamous bike shed and the runaway cost of the unfinished children’s hospital.

Seasonal Affective Disorder (SAD) is a type of depression that is experienced during the darker months of the year due to less hours of sunlight. It is a type of depression that follows a seasonal pattern and recurs at the same time each year.
Common symptoms associated with SAD include: low mood, sadness, hopelessness, and a lack of interest in daily life. Your energy may be low or you may have difficulty getting out of bed even after a good night’s sleep. Some of you find it difficult to stay awake during the day and have difficulty concentrating. You may feel like avoiding people and just being on your own.
If you are experiencing these types of symptoms, you could have Seasonal Affective Disorder and you may not realise that the lack of sunlight could be contributing to your symptoms. Things that may help include: exposure to as much daylight as you can, light therapy, gentle exercise, avoiding sugar and processed foods, and supplements may help.
Popular supplements are Vitamin D because lack of

sunlight leads decreased levels of this vitamin. Omega 3 Fatty Acids found in oily fish are associated with improved mood. Magnesium in general regulates mood and deficiency is associated with symptoms of depression.
The herb Rhodiola Rosea, Terranova brand, is another option and is one of my favourite herbs to to help with symptoms of SAD. It is an adaptogenic herb, this means that it may help the body adapt to physical, mental, and emotional stress, normalising the body’s response.
Over the years I have seen many customers experience the benefits of this herb with improvements in their mood, cognitive function, and ener-
gy. It is best to take Rhodiola early in the day and start with a low dose and build to the recommended dosage on the supplement. You can take it alongside Omega 3 fish oils, Vitamin D, Magnesium, or a multi vitamin that offers a variety of these nutrients. Seasonal Affective Disorder can be extremely debilitating and even more so if you already experience depression all year round. So, I hope that you find something that helps light up your day so you can feel good again. If you are on any medication, please check with your health care provider before taking supplements or herbs as they may interfere with your medication.

Parents today have challenges earlier generations of parents couldn’t imagine, like social media, mental health and wondering if your child will get bullied on or off line.
But parents in earlier generations had challenges today’s parents don’t. It’s doubtful there’s been any generation of parenting that lacked challenges.
At base, the parental generation with the lowest child mortality is probably the one under the least stress.
Parents in the ‘50s and ‘60s tended to ‘stay together for the sake of the children’ and so it was rare not to have both male and female parents living with the children.
Many now have to struggle in ‘share the children’ relationships.
All adults were allowed to chastise all children, an corporal punishment was the norm, and so child abuse was rife and ignored – parents just said “watch out for strange men” and let children roam freely.
Now it would be seen as irresponsible and so children need to be chaperoned and tracked, not only physically but online.
Learning was ‘facts by rote’ at school, with homework only at senior school. Now parents are doing homework with children from the start.
Today’s children seem to have many more options available to them, and each of the options seems to be rather more intensive than anything from precious childhood generations. Whether it’s sports or dance or whatever else, there seem to be many more competing for children’s limited time now.
And the rise of the internet means that children aren’t limited to finding a physical community with the peers who live on their street – they can find communities in whatever niche they prefer online.
Does that make parenting harder? It makes it more complex, which is harder
PHOTO: Charles Deluvio / Unsplash

from some points of view.
Perhaps, the hardest time for parenting was any time pre vaccination and pre modern medicine,when childbirth could routinely be a death sentence, and you had to be prepared that at least some of your children
would end up dying.
This discussion about parenting is maybe superficial.
Which one of us has tried to raise children in a war zone? Which one of us has tried to raise children in an area that has had famine?
Which one of us has tried to
raise children in a time of economic collapse?
Also, we have no idea what previous generations have experienced, much less what future generations will experience.
We can, to an extent, measure the inverse. Some-
contemporary children are raised by their grandparents because their parents aren’t available for one reason or another.
Not every one in the same generation has the same difficulties or challenges or advantages. Some have it much worse than the average, and some have it much better. There’s just too much variety in every generation, and too many individual circumstances across generations, to make meaningful generalised comparisons among the generations.
and
Fáil under Micheál Martin are almost neck-andneck, according to the latest poll.
Meanwhile, Sinn Féin has seen another drop in popularity.
The Business Post/Red C poll shows that, with the country set to head to the polls in the coming weeks, Fianna Fáil is up three percentage points to 21% while Fine Gael has dropped by a point to 22%. Sinn Féin dropped by one point in the

last month to 17%. This is down 10 percentage points from where the party was six months ago.
Among the smaller parties, support for the Social Democrats has dropped by one point to 5% while the Green Party has also dropped one point to 3%. Labour remains unchanged on 4%.
Support for independents remains unchanged at 15%, with support for Independent Ireland increasing one point to 5%.
People Before Profit-Soli-
darity remains on 3%, while Aontú has dropped one point to 3%.
Taoiseach Simon Harris [pictured] has confirmed that the election will take place before Christmas but has not yet confirmed a date. Friday, November 29, however, is the most favoured among the parties.
Green Party leader Roderic O’Gorman has already stated is his preferred date. It’s also understood this date is favoured by other senior Government ministers.


With the explosion of personal finance content on social media, millions worldwide, including those in Ireland, have turned to platforms like TikTok, Instagram, and Facebook for financial advice.
Known as ‘finfluencers’, these influencers provide guidance on everything from budgeting and saving to complex investment strategies.
According to research from the Banking and Payments Federation Ireland, 23% of Irish people under 35 use social media as a primary source of financial information, underscoring how widespread finfluencer impact has become.
For many, finfluencers offer a blend of entertainment and practical information that appeals to younger audiences looking for money tips. These personalities “bring a unique blend of authenticity, humour, and relatability to their content, resonating with audiences far beyond the country’s borders.” Yet, with
John Ellis
their rise comes an increased risk that followers might take the guidance at face value.
Although such advice may increase clicks, financial decisions usually demand careful, personal planning, which broad online tips cannot address.
Personal finance decisions vary from person to person.
As Barry Lenihan recently reported on RTÉ Radio 1’s Drivetime, “the financial priorities of a 55-year-old mortgage-free homeowner are vastly different from those of a 30-yearold new parent struggling with debt”. Despite this, many online advisors present their advice on a one-size-fits-all basis leading people to make unwise financial decisions without considering their personal circumstances.
For many, the engaging and easy-to-understand advice fills a void created by the perceived absence of accessible financial resources. However, the distinction between regulated financial advice and

casual guidance remains a crucial one.
Financial advisors in Ireland are regulated by the Central Bank of Ireland, which enforces consumer protection law, compensation schemes, and impartial advice through bodies like the Financial Services and Pensions Ombudsman. The unregulated nature of finfluencer advice, particularly in high-risk areas like investment, in the main lacks these protections, leaving consumers vulnerable.
Internationally, regulatory bodies have started taking steps to curb misinformation
and make finfluencers accountable. The European Securities and Markets Authority (ESMA) issued a statement recently reminding social media influencers of their obligations to provide credible and objective recommendations.
The UK’s Financial Conduct Authority (FCA) has teamed up with well-known influencers to promote safer financial practices while urging social media platforms like Instagram and TikTok to remove harmful, unlawful financial content. In Australia, the financial regulator demands that influencers discussing
financial products hold licenses and provide balanced, accurate information. This global regulatory momentum highlights the need for similar vigilance in Ireland.
Crypto assets represent a particularly volatile sector where finfluencer advice can lead followers into risky waters. The Central Bank has repeatedly warned against investments in crypto, labelling them as “highly risky and speculative” and highlighting the dangers of crypto promotions via social media. In fact, you currently cannot invest through your pension in crypto currencies.
The European Securities and Markets Authority recently cautioned that finfluencers incentivised to promote crypto may fail to adequately communicate the risks, focusing instead on potential gains.
For a sustainable solution, consumer financial literacy remains essential. Educating consumers who rely more heavily on social media for
financial advice, can help protect against the potential risks posed by finfluencers.
As the Competition and Consumer Protection Commission in Ireland pointed out in its 2022 Influencer Marketing Report, greater guidance on influencer marketing and responsible content is urgently needed. Strengthening regulations and offering educational resources are both crucial to ensuring that consumers can navigate online financial advice safely.
If you are seeking unbiased and professional financial advice, the best course of action is to consult a financial advisor who will tailor advice to your individual goals and circumstances. Personalised financial planning not only provides comprehensive, professional insights but also adds the peace of mind that social media soundbites cannot offer.
john@ellisfinancial.ie 086 8362633


Last weekend Bishop Niall Coll presented a series of awards to young people of St. Marys parish and Diocese of Ossory.
These John Paul II awards, named after the now sainted Pope, are a recognition of the commitment these young people have given to their faith in the parish and to the community in hours of volunteering outside of the parish activities.
There are 3 Award levels
– Gold, Silver & Bronze. In St Mary’s parish, Kate and
David both received the Gold Award recognising their commitment to the parish and community for the past year.
Parish priest at St Mary’s Dermot Ryan congratulated all recipients and thanked them forall they do and the manner in which they have do it.
“It is a joy to see our youth do so much work and always smiling and so happy to be helping others”, said Fr Dermot.
Fr Dermot also commented
that we don’t always teach young people - we can learn from them too.
On hand to present the awards was Bishop of Ossory Niall Coll.
Speaking at the evening mass at the Cathedral Bishop Niall said : “One of the ways in which the Church in Ireland tries to communicate Gods message to youth is through the Pope John Paul ll award, a programme well established in many dioceses”. Bishop Coll told the congregation that the church is committed
to helping young people to discover , rediscover and and grow in their experiences of life and faith.
“The youth are invited are invited to do so through participation in school, parishes, and community activities, which aim to enhance their spiritual, physical, emotional and social development”,
continued the Bishop.
The Pope John Paul ll Award supplements other outreaches by the Dioceses to young people which include pilgrimages to Lourdes, Medjugorje, and Taize.
In addition, many young people participate in diocesan liturgies , especially in St Mary’s. Cathedral, throughout the year. Significantly, such pastoral and liturgical engagementcan be include in the Jpll award. In conclusion Bishop Niall prayed that all involved with the scheme will find great source of blessing and encouragement.
Bishop Niall Coll with Gemma Mulligan , Diocesan Pastoral co-ordinator



The identification of new forms of cell death has sped up in recent years.
In necrosis, a cell dies by accident, releasing its contents and drawing immune cells to the site of damage by creating inflammation. In apoptosis, the cell collapses in on itself and the bits are cleared away without causing damaging inflammation.
Billions of cells die in your body every day. Some go out with a bang, others with a whimper.
They can die by accident if they’re injured or infected. Alternatively, should they outlive their natural lifespan or start to fail, they can carefully arrange for a desirable demise, with their remains neatly tidied away.
Originally, scientists thought those were the only two ways an animal cell could die, by accident or by that neat-andtidy version. But over the past couple of decades, researchers have racked up many more novel cellular death scenarios, some specific to certain cell types or situations.
Understanding this panoply of death modes could help scientists save good cells and kill bad ones, leading to treatments for infections, autoimmune diseases and cancer.
“There’s lots and lots of different flavors here,” says Michael Overholtzer, a cell biologist at Memorial Sloan Kettering Cancer Centre in New York. He estimates that there are now more than 20 different names to describe cell death varieties.
Lots of bad things can happen to cells: They get injured or burned, poisoned or starved of oxygen, infected by microbes or otherwise diseased. When a cell dies by accident, it’s called necrosis.
There are several necrosis types, none of them pretty: In the case of gangrene, when cells are starved for blood, cells rot away. In other in-
While human cases of bird flu remain rare, the virus’s spread among birds and now cattle increase the risk of exposure and infection.
A recent study discovered mutations in the bird flu genome that could give the virus the ability to better exploit certain mammalian proteins. Understanding potential paths for human transmission can offer crucial insights into monitoring the virus’s evolution and developing anti-influenza therapies.
A highly contagious bird flu epidemic has spread from continent to continent since 2020. It has killed hundreds of millions of wild birds and caused sporadic outbreaks among poultry. In recent months, the avian influenza strain that causes the disease (H5N1) has jumped to dairy cows, domestic cats, and even humans.
stances, dying cells liquefy, sometimes turning into yellow goop. Lung cells damaged by tuberculosis turn smushy and white — the technical name for this type, “caseous” necrosis, literally means “cheese-like.”
Any form of death other than necrosis is considered “programmed,” meaning it’s
carried out intentionally by the cell because it’s damaged or has outlived its usefulness. The two main categories of programmed cell death are “silent and violent,” says Thirumala-Devi Kanneganti, an immunologist at St Jude Children’s Research Hospital in Memphis, Tennessee. Apoptosis, first named in
1972, is the original silent type: It’s a neat, clean form of cell death that doesn’t wake the immune system. That’s handy when cells are damaged or have served out their purpose. Apoptosis allows tadpoles to discard tail cells when they become frogs, for example, or human embryos to dispose of the

Why needwe to keep tabs on bird flu
While bird flu in humans is a cause for concern, transmission remains fortunately rare. According to the World Health Organisation (WHO), only 896 cases have been reported worldwide between January 2003 and July 2024. That said, if cases of bird flu in humans continue to rise, it could mean the virus is getting better at infecting people. In a recent study published in Nature Com-
munications, researchers at the European Molecular Biology Laboratory (EMBL) discovered mutations in the bird flu genome that could give the virus this ability by allowing it to better exploit mammalian ANP32 proteins. Viruses are incapable of reproducing outside a host.
To make more of themselves, they must first invade a host cell and take over its cellular machinery. In the case of the bird flu virus, its polymerases — enzymes that make new copies of the virus genome — interact with ANP32 proteins to form a structure called the replication com-
the tissue tidy. Necroptosis and pyroptosis are the violent kinds, and they helped expand the cell death repertoire beyond apoptosis and necrosis. They’re often engaged when cells have been hijacked by viruses or other infectious agents. Rather than be reduced to virus factories, they kill themselves. These cells go down waving big red flags, in the form of chemicals they release to alert the immune system to come in and save their neighbours.
Immune cells, too, may need to die in the case of infection, inflammation or even cancer. As Kanneganti’s group investigated this process, they noticed an alternate mode of death that incorporated elements of apoptosis, necroptosis and pyroptosis. Using the first letter of each classic type, they dubbed it PANoptosis. Since then, researchers have found this hybrid death method in other kinds of cells, too.
webbing between developing fingers.
The cell shrinks and detaches from its neighbors. Genetic material in the nucleus breaks into pieces that scrunch together, and the nucleus itself fragments. The membrane bubbles and blisters, and the cell disintegrates. Other cells gobble up the bits, keeping
plex. As the name suggests, this complex is necessary for the virus to replicate. (In fact, in a different study, scientists used CRISPR gene-editing technology to engineer chickens resistant to bird flu. They did so by targeting the genes coding for ANP32 proteins.)
However, differences in avian and mammalian versions of this protein explain why avian influenza doesn’t typically infect mammals.
Specifically, the avian ANP32 has an amino acid tail that is missing in human ANP32.
Researchers have previously observed that virus particles could hold on to the avian ANP32 as they move from birds to mammals, possibly explaining some of the cases of avian flu in mammals. Even so, for the virus to be more successful in mammals, it must be able to use the mammalian ANP32 as effectively as the avian version.
To monitor the spread of avian influenza, the Centeres
In PANoptosis, the cell assembles a big protein machine called the PANoptosome. This activates enzymes to puncture the cell’s membranes. As it dies, the cell releases red-flag molecules that tell other immune cells there’s a problem. Why do cells need so many ways to achieve the same fatal end? Cells probably evolved these different options during an arms race with diseasecausing microbes, Kanneganti surmises. The microbes, aiming to survive, may try to turn off cell death. But if the cell has a wide menu of death mechanisms, it can commit suicide in another manner, sacrificing itself to thwart the pathogen. Ultimately, the study of life requires the investigation of cell death. As the Japanese author Haruki Murakami wrote: “Death exists, not as the opposite but as a part of life.
for Disease Control and Prevention in the US sequences viruses from samples obtained from infected animals in addition to tracking reports of illnesses and deaths. This is to trace mutations in the virus populations. The study establishes a link between the structure of the replication complex and adaptive mutations in the viral polymerases. Researchers could use this insight to determine if a particular bird flu virus strain is close to gaining the ability to infect people.
As bird flu continues to spread among birds and cattle, there will be more opportunities for the virus to jump to the humans who contact them. This is why experts suggest that more animals, and people around them, be checked for bird flu even in the absence of symptoms. Bird flu becoming the next pandemic is still an unlikely scenario as there is no evidence of human-to-human transmission of the virus.
1. Kayon Jungle Resort, Bali, Indonesia
Whether you’re seeking adventure or relaxation, The Kayon Jungle Resort offers a memorable experience. Perhaps the most enchanting aspect of this secluded jungle resort is its unparalleled access to nature. Explore the lush jungle trails on foot, accompanied by knowledgeable guides who will introduce you to the talented local community and tropical forest. You can take a refreshing dip in the resort’s infinity pool, overlooking the scenic Ceking Rice Terrace. Better yet, you can unwind on your private terrace, sipping a tropical cocktail as you watch the sunset paint the sky in hues of orange and pink.
2. Hanging Gardens of Bali, Indonesia
The Hanging Gardens of Bali is tucked in a lush rainforest overlooking the Ayung River. Accommodations here are nothing short of spectacular. Each jungle-inspired villa features a spacious terrace and floor-to-ceiling windows. For those seeking adventure, the Hanging Gardens of Bali offers several activities to explore the wonders of the surrounding wilderness. Visitors trek through lush rainforest trails, embark on a thrilling whitewater rafting excursion, and discover hidden temples nestled amidst the jungle foliage.
After a day of adventure, soak in any of the resort’s pools or enjoy a massage in the spa.
3. Mango Bay Resort, Vietnam
This jungle paradise offers something for everyone, so consider it if you visit Vietnam for a romantic getaway, family vacation, or solo adventure.
Tucked on the captivating shores of Phu Quoc Island, this resort is a good place to

the freshest seafood delicacies. For adventurous souls, Mango Bay Resort offers exciting activities to explore. Embark on a guided trek through the lush jungle, discover hidden waterfalls, or embark on a snorkelling adventure to witness the vibrant marine life thriving beneath the crystal-clear waters.
4. Wilderness Safaris Bisage Lodge, Rwanda Wilderness Safaris Bisage Lodge is a haven for those enchanted by the jungle’s allure. It offers an unparalleled experience amidst lush greenery and diverse wildlife of Rwanda’s volcanic landscape. This
jungle resort neighbours Volcanoes National Park, one of Africa’s oldest national parks. The park is home to endangered mountain gorillas, golden monkeys, over 200 bird species, and other wildlife.
After a day of exploration, return to any of the resort’s forest villas and unwind in tranquility with views of lush greenery.
5. Secret Bay, Dominica Secret Bay in Dominica is a charming all-villa rainforest resort that offers a perfect Caribbean escape. The facility’s secluded cliff-top location provides privacy and tranquility, with stunning views of the Caribbean Sea. Guests stay
in exquisite villas nestled among the trees, each designed to harmonise with the environment and provide the utmost comfort. These accommodations often feature covered terraces and private plunge pools, allowing guests to unwind and reconnect with Mother Nature.
At Secret Bay, adventure awaits around every corner. Guests can explore the surrounding jungle on guided hikes. Snorkeling, kayaking, and paddle boarding are popular activities for those seeking aquatic adventures.
6. Maruia River Retreat, New Zealand
A stay at Maruia River Retreat
is an opportunity to connect with New Zealand’s nature at its best. You’ll be captivated by the serene atmosphere during your stay. The air is filled with the soothing sounds of the surrounding forest, creating calming whispers of relaxation that wash over you like a gentle breeze.
Accommodations here are restful. Whether you opt for a villa with tree-top views or one overlooking the Maruia River, you’ll be immersed in comfort and relaxation.
Beyond relaxing villas, this resort offers a range of activities, including hiking and yoga. The activities are designed to help guests connect with nature and rejuvenate their spirits.
Mashpi Lodge, Ecuador Mashpi Lodge lets you unwind in a remote rainforest in the Andean Mountains. This facility’s rooms and suites feature floor-to-ceiling windows, allowing guests to feel truly immersed in their natural surroundings. At Mashpi Lodge, the possibilities for adventure are endless. From guided hikes through the forest to sky bike tours, guests explore the wonders of the cloud forest in exhilarating ways. For those seeking a more relaxed experience, yoga sessions amidst the tranquility of nature and bird-watching excursions offer moments of serenity and connection.
The Church Café Bar, Dublin’s stunning venue renowned for its Irish heritage and modern dining, has launched its guided tour. This engaging experience invites both locals and visitors to explore the rich history of Dublin and the unique venue itself, concluding with a traditional Irish coffee in hand.
Set within the architecture of a meticulously restored 18th-century church, the new tour offers a journey into the heart of The Church’s cultural and historical legacy. Led by our friendly guides, guests will be transported through key moments in Irish history, shedding light on the figures and events that helped shape the venue and Dublin. From its opening

in 1701, to the wedding of Arthur Guinness in 1761, and its transformation
into a vibrant bar and restaurant, The Church has witnessed over three centuries of Ireland’s history.
That’s not all, to complete the experience, the tour concludes with a traditional Irish Coffee demonstration—a delightful tribute to Ireland’s rich culinary heritage. Guests will learn about the craft of making this iconic drink, while having the opportunity to taste it for themselves, savouring every sip.
Renowned for its exceptional offerings, The Church Café Bar is more than just a venue—it is a living piece of Dublin’s history, now accessible
in an even deeper way through the guided tour. Visitors on the tour will explore all corners of this iconic building, from the main bar and restaurant to the hidden historic gems within its walls.
After the tour, guests can extend their experience by indulging in a delicious lunch, dinner, or special celebratory meal. With a menu that showcases traditional Irish dishes crafted from locally sourced ingredients, coeliac options, along with contemporary favourites and inventive cocktails, the venue offers something for every palate. Whether dining in the outdoor terrace, at the bar, or in the restaurant, The
Church offers the perfect place to relax and savour after a journey through Dublin’s past.
Tickets for this immersive experience can be purchased directly through the website Guided History Tour & Irish Coffee Experience - The Church and are priced at €15 per person. The ticket includes a complimentary Irish Coffee, and tours will run daily from 11am to 4pm, lasting approximately 45 minutes each. For an even more inclusive experience, the tour will be available in both English and Irish. Book your slot now to ensure your place on this unforgettable journey through Dublin’s history.

Halloween, pumpkin time, scary time. And am I scared? You bet. I am very scared –but not of ghosts, ghouls or wicked witches. I’m scared of what’s going to happen on Tuesday, November 5 in the US of A. Scared of how the folks over there are going to cast their votes. Are they going to give Kamala Harris the nod or are they going to tick the Trump box? It’ll be close. Very close. On a knife edge we’re told. And I am genuinely scared that Donald Trump will edge it just as Biden edged it four years ago – 0.03% that’s the percentage, I think, of votes that separated them. I am scared because I believe Donald Trump is dangerous, delusional and a threat to democracy. And so I might well turn, return I should say, to God to help get Kamala over the line.
In the meantime here are a few facts about American presidents. First off there have been close contests before: John F Kennedy, Democrat (the first Catholic President of the US) beat Richard Nixon, Republican, 49.94% to 49.77% in 1960.
*****
Lyndon Johnson (1963 –1968) succeeded Kennedy. Johnson’s family were all called LBJ – he was Lyndon Baines Johnson, his wife was Lady Bird Johnson, his two daughters Linda Bird Johnson and Lucy Baines Johnson while the dog was called Little Beagle Johnson.
*****
Every US president with a beard has been Republican including Abraham Lincoln, the 16th President
of the US who freed the slaves in 1863. Lincoln‘s mother died when the family dairy cow ate poisonous mushrooms and Mrs Lincoln drank the milk.
*****
Robert Todd Lincoln, son of Abraham, was present at the assassination of three US presidents: Lincoln, Garfield and McKinley.
*****
John Quincy Adams, the sixth president of the US had a pet alligator which he kept in the White House. He swam in the Potomac River every morning – naked.
*****
Gerald Ford and Bill Clinton were both adopted.
*****

Gerald Ford was the only president never to have been elected as president or vice-president.
*****
James Madison (1809 –1817) was the first president to wear long trousers; all the previous presidents wore knee breeches.
*****
And so to switch subject. Two days after Halloween Christian faiths celebrate All Souls Day when they believe that the souls in Purgatory are released to their loved ones for one night.
I have great affection for that belief as it led to me having my very first poem published in the New Irish Writing page of the Irish Press, edited by David Marcus who launched the careers of numerous
well-known Irish writers and who gave me the confidence that I could write – something I’m still doing almost 50 years later.
The year was 1977 and I had just come home after a few pints in Mickey Brennan’s (now The Field) my local at the time. I sat with my mother for a while and this is what ensued:
All Souls Night
It’s late
Time for bed and dreams
My mother tidies, sweeps: ‘Put a block on the fire, boy
The poor souls will be here tonight.’
They’ll not be cold I tell myself: my father, Aunts Katie, Lizzy And my mother’s mother Whom I never knew.
They will be welcome
At this warm hearth
Where once they aired
Our vests and socks
Fresh smelling wool and cotton
For our Saturday night Bath- night skin.
My father’s chair is empty, waiting I can hear his cough, smell
The cigarette end between his thumb
And burnt forefinger, as he turns
Another page of some old yellowed Western, a smile all over His engrossed face.
I don’t suppose It happens really I do and don’t believe
But just in case
The block is on And lighting And everything’s right.

Event Details
Time: Saturday
2nd and Sunday
3rd November 2024 (12.00 pm to 3.00 pm)
Place: Tholsel, Kilkenny Town Hall, High Street, Kilkenny
Locals and tourists are invited to honour the memory of Petronilla de Meath, the alleged maid to Dame Alice Kyteler, who was persecuted and executed for witchcraft 700 years ago. In 1324, Petronilla was tortured under Church Law until she confessed to heresy and witchcraft, becoming the first woman in history to be burned alive at the stake on 3rd November.

The event, commemorating Petronilla’s life, is set to unfold over two days, allowing the public to reflect on her story and those of others who have endured persecution, both in the past and in the present. By tying brown paper tags with the names of individuals who have suffered injustices, have been forgotten by history, and those we’d like to honour, onto the wrought iron railings of the Tholsel (Town Hall), High Street, Kilkenny, this personal act serves as a tribute to her memory. It becomes an expression of solidarity and remembrance for those who have faced wrongful persecution too.
This event, organised by artist Pauline O’Connell and curator Rachel Botha, invites
participants to gather in reflection and respect, and serves as a call for justice, inspired by Petronilla de Meath’s life. As an icon of resilience and a symbol of intersectional feminism, Petronilla’s story remains a powerful testament to the ongoing fight for equality, justice, and dignity for all who have been silenced or erased by societal, religious, or state institutions.
The public is invited to join in marking this significant anniversary as it creates an opportunity to honour those who have suffered at the hands of unjust institutions and practices. Through this shared moment, participants will engage in a collective remembrance of the past and take a stand against ongoing injustice.
This event is free and open to all. Let us come together to commemorate these stories and elevate the voices of those who have been silenced, invisibilised, and erased from history

The legend that is Johnny McEvoy
The term 'living legend' is sometimes loosely accredited to artists in the music business, but certainly not when people speak about Johnny McEvoy. Johnny has always been highly acclaimed for the quality of his live concert shows and when his Autumn tour 2024 was announced, it received a huge response from his legion of fans nationwide as with Covid and its consequences, he hasn't toured for the past 4 years.
His current live show is called 'A Nostalgic Evening of “Song and Story”' and features all of Johnny's 'Hit' songs, including Mursheen Durkin, Boston Burglar, Long Before Your Time, Rich Man's Garden, Michael Collins etc., many of these songs penned by Johnny. His songs are hauntingly beautiful and evocative, always presented with an
individuality that is unmistakably his own unique style. One can truthfully state that Johnny McEvoy has been one of the most enduring and talented singer songwriters in the Folk/Ballad genre in Ireland over the past 50 years. His concert performances are second to none and incorporate a brief but relevant reference to the story of each song. The lyrical clarity of Johnny's vocals combined with gentle backing from excellent musicians is a joy to listen to and ensures a wonderful and joyful evening of 'Song and Story'. Join Johnny McEvoy in Hotel Kilkenny this Saturday 2nd November at 8pm.
Tickets can be bought at the Hotel, Ticketmaster or you can pay at the door on the night.

Manager Jackie O’Neill was in the vanguard of some of her many Radio Stars that captivate the people of Kilkenny on a weekly basis on Kilkenny’s only Community Radio as they travelled to the Craol National Community Radio Awards in the sumptuous Carrickdale Hotel in Dundalk on Friday evening last.
A very palpable air of expectation cloaked the party as they travelled the 3-hour journey to the Co. Louth
venue. Chairman of the CRKC Board, Maurice O’Connor was quietly confident that the group might return with an Award or two. Manager Jackie was nervously reticent about the prospects of winning, because as she remarked in a pre-Ceremony interview, “we have been presenting very fine Radio in Kilkenny, and if the appreciation and acclaim of our own Kilkenny people was any form of a barometer, I have a sense that we will certainly not return from this
prestigious National Awards Ceremony empty handed”. And how on the ball her expectations morphed to reality.
As the packed expectant audience waited for the ‘white smoke’, the Kilkenny contingent were more than bullish about their chances of getting into the winners enclosure.
They didn’t have too long to wait as one of their marquee programmes Birds on the Wire creamed the Gold Award for
Commissioned programmes. And how the “Birds” -Claire Henriques and Nicola Brennan reacted as they whooped their way to the presentation rostrum accompanied by the Station Manager, a beaming Jackie O’Neill.
Contributors Treacy Millea, Caroline Lee, Cecilia Shefflin, Colette Shannon, Regina Blundon, Sinead O’Callaghan, Marion Gaffney, Maeve O’Flynn, Kevina Hayes, Karol Knox and Patsy Cummins who have made brilliantly entertaining contributions to the programme since its inception were thrilled with the Award when news filtered through to Kilkenny.
Community Radio Kilkenny City were only getting started in the County Louth Hotel! The next category was about
inclusivity, diversity and access to the Community served by the local Radios, and the contribution rendered via outside broadcasting units. CRKC won the Gold Award, and presenters like DJ Don Devlin and current affairs guru, Frank Tynan accompanied by Mick Cummins and Station Manager, Jackie, were bouncing as they collected the Award from the stage. Kilkenny’s only Community Radio serving its own Kilkenny people were not finished yet. The Irish Language Award “Clár na gCairteacha ar Radio Pobail” also got into the winner’s enclosure. The Programme, is presented by a new addition to the Community Radio, Thomas Morris on Thursday evenings at 8pm.

As Thomas was indisposed, the silver Trophy was collected by the so proud Station Manager, Jackie. But the creme de la creme was yet to come. The overall ‘Oscar’ for the evening, the Craol Achievement Award was given to the Birds on the Wire programme. The celebrations at the Kilkenny table knew no bounds. It was a hugely popular achievement. Led by the Manager, they ‘sambaad’ their day to the presentation rostrum, much to the acclaim of the gathered audience.
Community Radio must be doing something right. With over 60 volunteers, and a few employees, the Craol Awards system is evidence of the quality and abilities of it’s staff. Its re-incarnation has been a revelation in Broadcasting. It truly has hit the spot. Its popularity graph has been a steady upward journey. Its widening 24-hour schedule finds listeners over a multi-faceted programme. It certainly does what it says on the tin ‘community front and centre’.
As the old sean fhocal runs – Ar aigh le misneach agus le chéile (Go forward with courage and together). It certainly looks like Community Radio Kilkenny City subscribe to that sean fhocal.

Just days out from the US Presidential election let’s take a satirical look at what might be happening at the rival campaign headquarters as the votes come in.
In the busy offices of opposing campaign teams, the excitement around the election is increasing. Balloons float around, representing high hopes that seem to reduce as time passes. An intern jokingly asks how often the predictions will change today. Another intern predicts perhaps three more changes before lunchtime. Anxious team members hold large coffee cups. A campaign manager remarks they have taken an extra shot of espresso, just to be prepared. There is a mixture of nervous laughter and quiet conversations as optimism clashes with anxiety.
In the busy campaign office, there is a lot of energy. Julia, the fifth intern,
jokingly calls the unopened champagne “aspirational decor” and adds: “One day, we’ll open these!” Sam smiles awkwardly as glitterconfetti accidentally goes off again, covering a desk with sparkle. The speechwriting team is revising drafts with enthusiasm. “No, that doesn’t capture the message,” Marco insists. Amy lets out a sigh, adding another draft to the discarded pile, thinking they need to start over.
As the event approaches, the headquarters are filled with technological challenges. The Wi-Fi is constantly disconnecting, causing frustration among the team. One person humorously suggests that the internet is working against them as they refresh their screen repeatedly. Phone reception is just as poor, with a volunteer loudly asking if they can be heard while searching for a better connection. Compet-

ing advertisements disrupt the livestream, creating some unexpected humour. Despite these obstacles, the volunteers manage their tasks with determination and impressive composure. As the last hours approach, the campaign headquarters are busy and offer some comfort. The smell of pizza

fills the room, providing much-needed energy for those who have given up on healthy meals. Emily, the communications director, eats a slice of pepperoni pizza and remarks: “Calories on election night don’t count, right?” The abundant pizza boxes and numerous empty coffee cups help
power the team, mixed with moments of laughter and brief attempts at relaxation.
As time passes, the headquarters turn increasingly busy. Music plays while Mark suggests that Eye Of The Tiger is suitable, and Sarah responds with We Will Rock You’ as a better choice. There is no mention of Southern Man or Hometown Alabama.
Volunteers receive encouragement through notes.
Keyboards make noise as Jessica says: “There are more figures to analyse,” while typing quickly. Chris occasionally sighs, showing signs of fatigue. Volunteers sing quietly, imagining success as the mix of music and work creates a unique environment.
As time progresses, there is a mix of hope and urgency in the atmosphere. The air feels electric, and the tension is noticeable as results come in, possibly indicating
success or failure. The scene resembles a lively event where opposing groups exchange glances. There are jokes about “apocalypse bingo” and “wild optimism”. Despite this, a sense of togetherness remains, with a collective hope that the future could bring significant change. As the election night unfolds, we are captivated by its unpredictability. Jane watches the screen in disbelief, while Tom laughs. Their shared laughter reflects the essence of democracy. Slogans disappear, leaving behind a sense of comedic disorder. A volunteer hesitantly types, “Is anyone else feeling anxious?” Another person responds: “Welcome to politics!” As the vote counts come through, we accept the chaos with a smile, recognising that humour keeps us interested. Not much different to a Kilkenny election?


A special event hosted by Local Enterprise Offices Carlow and Kilkenny to celebrate women in business on National Women’s Enterprise Day 2024 was a huge success by attendees, connecting over 130 female entrepreneurs at the Woodford Dolmen Hotel, Carlow. The event featured inspiring discussions, networking opportunities, and insights from successful female leaders, highlighting the power of women supporting women in business.
The event’s keynote address was delivered by Sinead O’Brien, founder of Sinead’s Curvy Style, who captivated the audience with her entrepreneurial journey of building the shapewear brand VACIOUS. She spoke about the importance of resilience, selfbelief, and building a brand that empowers others.
A feature of this year’s event was the ‘Women Supporting Women Panel’ facilitated by Shonagh Lyons, host of the Beat 102-103 Breakfast Show. The panel featured a remarkable line-up of female leaders including Irene Frisby, Managing Director of FQS and National Womens Enterprise Day Ambassador for Carlow/Kilkenny; Linda Codoul, President
of Network Ireland; Rosemary Ward, Deputy CEO of Propelor BIC; Kate Gaynor, Managing Director of Ad -
vanced Coatings and Sinead O’Brien, Founder of Sinead’s Curvy Style. The panel shared valuable insights
on leadership, collaboration, and mentorship. They shared the importance of women supporting women

and emphasised the role of mentorship in overcoming challenges and driving business success.
Cllr. Fergal Browne, Cathaoirleach of Carlow County Council, praised the initiative saying "National Women's Enterprise Day is a key event that showcases the incredible contributions women make to our economy and local communities throughout the country. The success stories shared today highlight the resilience, creativity, and determination of female entrepreneurs across Carlow and Kilkenny.” Cllr. Browne continued to say, “It is vital that we continue to support initiatives like National Women’s Enterprise Day, which not only inspire but actively provide the tools and resources women need to excel in business”.
Melissa Doyle, Business Advisor with Local Enterprise Office Carlow stated, “National Women's Enterprise Day 2024 is a testament to the incredible potential of female entrepreneurs, and we are proud to support their journeys through a range of services and resources. At the Local Enterprise Office, we are committed to providing ongoing support, whether through mentoring, training programmes, networking events or financial assistance, so that women can not only launch their businesses but also scale them successfully."
Aisling Carey, Business Advisor in Local Enterprise Office Kilkenny highlighted the importance of such initiatives, "National Women’s Enterprise Day is not just about inspiration, it is about creating meaningful connections that will help women grow their businesses. By bringing together leaders who have achieved success and others who are on their entrepreneurial journey, we create a community where everyone can thrive”.
National Women’s Enterprise Day 2024 highlighted the important role that Local Enterprise Offices play in supporting female entrepreneurs. By offering valuable services such as mentoring, training programmes, financial assistance, and networking opportunities, the Local Enterprise Offices provide women with the tools they need to overcome challenges and grow their businesses. Ongoing investment in these resources not only strengthen women-led businesses but also create a positive economic impact in our communities.

Over the last 30 years, Market Cross Shopping Centre has been a cornerstone of Kilkenny’s vibrant retail and social scene, making invaluable contributions to the community. Since opening, it has offered a diverse range of shops, eateries, and services that cater to locals and visitors alike, creating a lively, accessible space in the heart of the city. By attracting well-known brands and local businesses, Market Cross has boosted Kilkenny’s economy, providing job opportunities and fostering a bustling retail environment.
The shopping centre has also become a social hub, regularly hosting community events, seasonal celebrations, and charity fundraisers that bring people together and strengthen community bonds. Its convenient central location and welcoming atmosphere have made it a go-to destination for family outings, shopping trips, and casual gatherings. As Market Cross celebrates 30 years, it stands as a testament to its role in supporting Kilkenny’s growth and creating memorable experiences for residents and visitors alike.
The units of Market Cross Shopping Centre are thrilled to join in celebrating Market Cross’ 30th birthday! This milestone highlights the dedication of each unit to providing quality products, friendly service, and a welcoming atmosphere. As they celebrate this landmark year, the units look forward to creating even more memorable experiences and continuing to be a central part of life in Kilkenny. Cheers to 30 years of Market Cross— and to many more!
Peter Mark: has been a trusted name in hairdressing in Kilkenny for many years, serving the community with expertise and style. Known for its skilled team of stylists and commitment to quality service, the salon has become a staple for Kilkenny locals and visitors seeking profes-
sional hair care. Peter Mark is excited to join in celebrating Market Cross Shopping Centre’s 30-year anniversary, marking three decades of service and community in the heart of Kilkenny. As one of the original tenants when Market Cross opened 30 years ago, Peter Mark has been a part of Market Cross from the very beginning, building strong relationships with local clients and growing alongside the centre itself. As they celebrate this milestone, the team at Peter Mark looks forward to many more years of helping clients look and feel their best.
The House of Pretzels: is a popular destination for anyone looking for a fresh, deliciously handmade snack. The small bakery specialises in authentic, hand-rolled pretzels with a unique variety of sweet and savoury flavours. The madefrom-scratch products come in a variety of savoury forms like pretzel burgers, pretzel dogs, ham and cheese rolls or the various calzones. The best selling pretzels also come in a variety of flavours such as cinnamon, ginger, seeds, plain or salted. Bringing the pretzels to the next level for people with a sweet tooth, they also have Belgian chocolate dipped pretzels, donut pretzels and chocolate donuts. When you have had enough of the pretzel range, other sweet options include big chocolate chip cookies, muffins, and pastries. You will always find different hot and cold drinks, perfect for pairing with their warm freshly baked goods either in the cosy indoor seating area, or the generous outdoor seating area. Since 2011, The House of Pretzels has been an integral part of Market Cross and is delighted to be able to celebrate such a big milestone with them!
Vero Moda: is a stylish and contemporary women’s fashion store that offers a range of trendy and versatile clothing. Known for its chic European



designs and focus on quality, Vero Moda appeals to a wide age range, with pieces that transition seamlessly from casual wear to more formal attire. The Kilkenny store in Market Cross shopping centre showcases a mix of classic
basics and seasonal collections, making it a go-to spot for women seeking fashionable yet affordable options. Shoppers can find a variety of items, from cosy knits and sleek outerwear to dresses and denim that reflect current

fashion trends. Being a staple in Market Cross for years, Vero Moda are happy to have the opportunity to celebrate this momentous success with them!
Nolan’s Jewellers: Having traded at Market Cross Shopping Centre for 11 successful years, it’s a great privilege to be a part of the Market Cross Shopping Centre family and the 30-year anniversary. With characters and entrepreneurs such as Fergal Quinn and



Bobby Kerr, applying their trade in this shopping centre, the Nolan family are very proud to be operating in a retail space with such a rich history and with an exciting future. We look forward to the next 30 years with a great sense of optimism and wish all our fellow retailers the very best of luck in the upcoming busy season. From all the team at Nolans Jewellers.
Pierce of Ink: is a professional shop concerned with

customer safety and satisfaction. They pride themselves on offering a professional service in a friendly atmosphere with staff that work hard to provide their customers with high quality tattoos and piercings. In their offer you can find a wide range of services associated with tattoos, body piercing and the biggest choice of piercing body jewellery in Ireland. Pierce of Ink offers a range of styles, from intricate line work to bold, colourful pieces, ensuring each client’s vision is uniquely brought to life. The experienced artists at Pierce of Ink work closely with clients to create meaningful designs, whether for a first tattoo or a new addition for seasoned tattoo enthusiasts. Situated above R95 Male Grooming, Pierce of Ink are delighted to be a part of the community in Market Cross and look forward to celebrating with them.
Asia Deli & Dessert: is a culinary gem offering a unique blend of Asian-inspired dishes and indulgent desserts. Known for its diverse menu, the deli serves everything from savoury food to sweet treats that cater to a wide variety of tastes. For a tasty lunch, try their handmade sandwiches paired with a freshly roasted coffee. For those with


a sweet tooth, Asia Deli and Dessert also serves a selection of delightful desserts, including bubble teas, pastries, and creamy ice cream. The friendly, welcoming atmosphere and fast service make it an ideal spot for a quick lunch or a sweet snack break during a busy shopping day. The owners moved over from Ukraine and started fresh in Market Cross by creating Asia Deli & Dessert. Being a newcomer to Market Cross, Asia Deli & Dessert are excited to be a part of the great community that Market Cross creates.
The Natural Health Store: are thrilled to celebrate with you as Market Cross Shopping Centre turns 30! Join them on 8th November for Market Cross’s Ultimate Customer Appreciation Day. Over €1,000 in prizes will be up for grabs in-store with their Buzzer Competition and on air with Mick Cummins on Community Radio Kilkenny City from 12-3pm. Be at the till when the buzzer sounds, and you could win a prize worth between €10 and €200. Spin the Wheel with Trilogy for a chance to win a full Trilogy product, and enter the raffle to win a Viridian Hamper worth over €200, packed with ethical, pure supplements for vitality and immunity. Meet

experts from Terranova, Irish Botanica Herbs, Mus Mór, and Spoonful Botanica, and enjoy samples in-store. Their customers are at the heart of everything they do - so go celebrate with them on 8th November!
Join Market Cross on the 8th November for their ultimate customer appreciation
day to celebrate 30 years of serving the community. With lots of special events and prizes up for grabs, it’s a day you don’t want to miss. As an extra special thank you, from 8th - 29th November, enjoy your 3rd hour of parking for FREE! They look forward to seeing you next Friday for our big birthday bash!



BY JOHN FITZGERALD

Duiske Abbey stands as a monument to Ireland’s long association with monastic orders. It has the distinction of being the largest Cistercian church in the country and one of the first Gothic structures to appear on the Irish landscape. In recent years, it has become renowned for the quality of its world acclaimed musical recitals.
The abbey is also a masterpiece of restoration. Remnants of the original 13th Century tiled floor can still be detected, and a magnificent oak roof shelters all who worship within its hallowed walls. A beautifully crafted Romanesque door can be seen on the South Transept. In the abbey grounds you can admire the monks’ creative genius in the form of two granite High crosses, dating to the 8th and 9th centuries. In about 1204, Cistercian monks founded the abbey, after the Normans introduced this hard working, agricultur-
ally motivated spiritual order to Ireland. The settlement that grew up around these industrious men came to be known as Graige-na managh-the Village of the Monks, a name it has retained to this day.
The abbey was ideally situated close to the Black Water, a small stream that flows into the River Barrow.
The story of the abbey began 24 years earlier, in 1180, when the powerful Irish Chieftain, Dermot O’ Ryan, declared his intention to build a monastery at the site dedicated to “God, Saint Mary, and Benedict.” His ambition was not realized,
however, owing to complex political and military events arising from the Norman invasion of Ireland.
But the Normans proved equally committed to the promo tion of Christianity, and the Cistercian Order was encouraged to create a settlement at what became the village of Grai-
guenamanagh. A wooden cross was hoisted and work began on the building of St. Saviour’s Cistercian Abbey. It took thirty years to build the Monastery.
The fifty or so monks who moved in to the abbey upon its completion put their agricultural prowess to good use from day one, raising huge flocks of sheep and running a woollen mill from which wool was exported to the Continent.
And they harvested salmon and eels from the river.
For three centuries, the abbey and the farm thrived, bringing both economic and spiritual nourishment to the Village of the Monks. But in 1536, King Henry VIII dissolved the abbeys of Ireland. The great abbey of Duiske fell into disrepair and the kindly monks were forced to flee for their lives. But they returned at a later date to resume their valued service to

the community.
However, it was not until the 1970s that restoration of the church began, and what you see today is a tribute both to the Cistercian Order and the enterprising spirit of locals who saw to it that their unique heritage would be valued and preserved for future generations.
And the abbey’s musical image is worth a mention. I particularly enjoyed a performance 22 years ago by Joe Burke, who revived interest in the accordion, and the haunting sound of the uilleann pipes played by Michael Cooney, a talented Kilkenny musician. The orchestral works performed at the abbey have an added appeal thanks to the medieval aura of “a time beyond recall” that pervades the building.
Even old King Henry VIII, who had an ear for music, might have thought twice about shutting down the abbey if had heard a recital at Duiske!

Kilkenny County Council was delighted to announce the launch of a series of Green Case Study videos on October 24th to celebrate International Day of Climate Action 2024.
The initiative – which was run through the Local Enterprise Office – was undertaken to highlight the challenges faced by business in the sustainability journey, and also to showcase the fantastic progress that has been made to date by business in the county.
Four businesses of varied types and sizes participated in this initiative, and the video output demonstrates the success that can be achieved in the green transformation through small steps in the right direction and ongoing commitment to change.
Martin Costello of Murphy Jewellers on High Street Kilkenny outlines the initiatives that have worked for the business including zoned heating and the move to LED lighting, while Liam Walsh of Peter Walsh & Sons, Three Castles describes the savings that the introduction of a biomass
plant and solar farm have generated.
Gareth Connolly of Connolly’s Red Mills gives a tour of the reed bed created in their Goresbridge Headquarters which captures waste water and acts as its own natural habitat, and Nicholas Mosse shows the turbines that have been in operation for more than 100 years in the mill site dating back to the 1750s where his grandfather ran a flour mill and where Nicholas Mosse pottery now operates from. Cathaoirleach of Kilkenny County Council Michael McCarthy noted at the launch event “it’s inspiring to meet with businesses who have made such an investment in sustainability to date. These videos created through the Local Enterprise Office demonstrate the commitment to the green transformation across the county and show the forward-thinking nature of business in Kilkenny” The videos are available to view on Kilkenny County Council’s YouTube channel and the investkilkenny. ie website. kilkennycoco - YouTube www.investkilkenny.ie




By Ger Cody Photos: jbs photos kilkenny
Like many cities and towns in Ireland, Kilkenny is blessed to have at its disposable a mountain of recorded history that people can access.
Be it the construction of your family tree, history of your local GAA club, or information on historical facts that occurred in Kilkenny, amenities are available in ‘Ye Faire Citie’ to satisfy your curiosity.
There are many, mostly volunteers, to whom we owe a debt of gratitude for satisfying our lust for information from yesteryear.
We think of our wonderful library service, formerly of John Quay, now at the Mayfair, and of course the wonderful Rothe Hose.
Information from days of yore can also be be garnered form Kilkenny Castle, Kilkenny County Council and The Kilkenny Great war memorial group.
We can now add two names to that august group as a means of tracking our rich Kilkenny Heritage. Enter the father and son team of Eamon and Paul O’Toole.
Although no longer with us, Eamon spent a large


portion of his life travelling Ireland and collecting postcards which he purchased at various sales, car boot sales and fairs. An absolutely

magnificent selection of cards that show Kilkenny in all its pictorial glory.
Eamon will also be remembered for many years of service as a valued employee of Crotty’s bakery on Parliament Street.
He will also be remembered fondly for his work at Kilkenny’s Brewery Club.
And now, thanks to Eamon and his son Paul, this collection was exhibited recently at a Culture night exhibition at Ryans Bar on Friary Street. And as the event was a mere stones throw from the Observer office, needless to say we attended.
The significance and importance of the O’ Toole collection is massive, not

just for the family but for Kilkenny itself.
The Kilkenny Observer spoke with Una Lennon at the TASK art studio where where Paul practises his art.
Said Una: "Paul is one of our studio artists in the TASK art studio in the Auxiliary hospital. Pauls background in draughting and architectural design drawing is very evident in his artwork.
You can see both modernist and futurist influences. His interest in buildings, old and new, came from his late dad Eamon."
When Paul first showed his dad's postcard collection of postcards to Una, she was intrigued, not just by the images, but by Mr. O' Toole's
pride in Kilkenny - travelling to fairs and car boot sales over the years, determined to find old images to collect.
“In an age of 'online shopping' and 'next day delivery', it would be easy to forget the dedication of previous generations and the lengths that they went to, to collect and preserve such gems" continued Una.
Ms Lennon told this paper that It was important to showcase this collection.
"The event that we had for Culture Night in Ryans was a great success - conversations flowed, and memories were shared about the people and places of Kilkenny" said a delighted Una. And it would appear that the showing at

Ryan's is not the end of the story.
"We are hoping to showcase the collection again in the near future so that many more can come and appreciate historic Kilkenny, so watch this space" advised Una.
Paul also paid thanks to TASK in general and to Una and Cathal in particular.
“Both Una and Cathal supported my idea of displaying my fathers collection from day one and I cannot thank them enough for all they have done” said a delighted Paul.
One can confidently state that Mr O’Toole’s hundreds of man hours spent collecting these cards and


sands of miles spent traversing the country in his Nissan Pulsar or his Toyota Corina cars has certainly left a legacy to shout from the tree tops. These photographs can provide glimpses into lives past, long-ago events, and forgotten places. They can help shape our understanding of culture, history, and the identity of the people who appear in them.
We at the Observer noticed that on the night of the exhibition, Many people in attendance marvelled at the postcards on display creating a conversation of a life and time long since gone. Let us hope that this postcard exhibition, curated by Paul O’ Toole will travel further in the years ahead.















US Justice Department attorneys have written to Attorney General Merrick Garland, calling out the “glaring gap” between the department’s approach to crimes committed by Russia and Hamas — versus the department’s silence on potential crimes committed by Israeli forces and civilians.
The four-page letter explicitly calls on the department to investigate potential crimes committed by Israeli soldiers and civilians, including the killings of American citizens in the West Bank and Gaza.
“In prosecuting crimes committed by Russia, Hamas and other wrongdoers, the department has appropriately demonstrated its commitment to upholding the rule of law in the midst of ongoing geopolitical conflicts,” the letter says. “But against the backdrop of numerous potential violations of US law by individuals and entities affiliated with Israel, the department’s silence and apparent inaction is a stark omission.”
The letter, which was first reported by Zeteo, a new media organisation on Substack, is a rare instance of public disagreement from within the Justice Department. Unlike at the State Department, there is no established internal channel for DOJ employees to express dissent over a policy issue.
NPR reported two weeks ago on the Justice Department’s silence over four US citizens killed this year in the West Bank and Gaza Strip — the victims’ families say by Israelis — despite demands from the Americans’ families that the department investigate.
The DOJ letter was anonymously signed “your colleagues.”
NPR has confirmed that the three authors of the letter are mid-career attorneys at the Justice Department, two of whom work at department headquarters in Washington, D.C.
It’s unclear how widespread the views expressed in the letter are among the approximately 10,000 attorneys who work at the US Justice Department, or what impact it could

have. One of the authors, speaking on condition of anonymity due to concerns about potential professional retaliation, told NPR the letter was from a non-department email account to a senior official in the attorney general’s office.
The Justice Department declined to comment for this story.
During his time as attorney general, Garland has frequently spoken about upholding norms and “treating like cases alike.” That was the
theme of a major speech he delivered in the department’s Great Hall to the DOJ workforce on September 12.
In that speech, the letter says, Garland told the department’s employees that “as attorneys for the government, we should not be influenced by, among other factors, a person’s background, our feelings concerning the victims, and the effect of a charging decision on our professional and personal circumstances.”
The letter also raises remarks
Garland made after Congress passed the Justice for Victims of War Crimes Act in 2022, which allows the department to prosecute a suspected war criminal in the US, regardless of the individual’s nationality.
“In the United States of America, there must be no hiding place for war criminals and no safe haven for those who commit such atrocities,” Garland said at the time.
“This bill will help the Justice Department fullfil that important mandate.”
Since Russia invaded Ukraine, the US has changed its laws on prosecuting war crimes
After Russia’s full-scale invasion of Ukraine, Garland publicly condemned the “war crimes that the entire world has seen,” and set up a special team to focus on possible Russian atrocities. The department has since charged four Russian soldiers with war crimes in Ukraine for allegedly abducting and torturing an American citizen.
In the Israel-Hamas conflict, Garland has publicly confirmed the department is investigating the killing and kidnapping of Americans in Hamas’ October 7 attack on Israel.
The department also has brought terrorism charges against six Hamas leaders. But, the letter says, there has been a “glaring gap” in the department’s enforcement of potential violations of U.S. law by Israeli government forces and citizens.
Israel’s targeting of peacekeepers in Lebanon is nothing short of a war crime, and “we don’t have to fudge the language about it”, a security expert has said.
Shelly Dean, a researcher at UCD’s School of Law and Government told The Explainer podcast that the recent attacks on Unifil observation posts breach international law. Irish troops are deployed under the United Nations Interim Force in Lebanon.
It’s Ireland’s largest overseas deployment as part of a joint Irish and Polish Battalion, including a contingent from Hungary and Malta.
“You don’t target observation posts, you don’t target
UN compounds. It’s not what we do,” said Dean.
“The difficulty, of course, is that there’s no broker to convince the Israelis to recalibrate their decision making.”
US Secretary of State Antony Blinken told Lebanon’s prime minister that the safety of peacekeepers is “essential” and has called for a diplomatic resolution to Israel’s offensive. But little action has been taken by the superpower.
Dean says the timing of the conflict – erupting a year before the US presidential election – has meant key players in politics are reluctant to make any big moves that may hurt them at the polls.
The Israeli military has yet
again fired at a United Nations observation post in Lebanon.
Separately, peacekeepers reported three incidents of unidentified fire impacting Unifil positions, teams and vehicles this week, adding no peacekeepers were hurt but calling the security situation “extremely challenging”.
Earlier last month, Israeli tanks destroyed the entrance to a peacekeepers’ camp in Lebanon and “forcibly entered” the position in what Unifil called “shocking violations”.
Ghanaian troops were injured in the incident, but Irish soldiers were unharmed at the time.
Israeli Prime Minister Ben-
jamin Netanyahu called for peacekeepers to retreat if they want to stay out of “harm’s way”, but Dean says that’s not the solution.
“The challenge there is that Unifil is there to fulfill a particular role, which is to maintain this space so that neither protagonist gets to run over there and physically create a changing on the ground,” she said.
“If facts change on the ground and Unifil were to withdraw any attempt to remedy the situation would take doubly long, not least because that space is would have been diminished.
“We can’t afford to jeopardise things even further.”
Dean says Irish peacekeepers, although not the largest contingent, have been essential to fulfilling the UN’s mandate in south Lebanon.
“The role of moderation and mediation between parties and building relationships with local communities is often deemed to be, by many, soft security.
“We’re very good at chatting with the local people and creating camaraderie and building relationships, but that’s fundamental and essential for any kind of restoration reconciliation.”
She said due to imprinting of cultures on each other, the Irish and the Lebanese “get on very well”.
What the Irish troops have is called “smart power”. Rather than being combative, they de-escalate situations, which is vital in a place where “a car accident has political ramifications if it’s the wrong people in the car accident”.
Having had a presence in the area since 1978, relationships have been built over generations.
“Some of the peacekeepers that you speak to will tell you that when they’ve gone on various tours ... the little children that you gave sweets to, say, a decade ago might well be far more important and have affiliations that can be very beneficial,” said Shelly Dean.



The Kilkenny Involvement Centre and Recovery College South East have produced a wonderful anthology of poetry and prose. ‘White Twine and old suitcases’ comprises of 128 pages and 60 authors and is complemented by some wonderful photos and artwork by TASK camera club. It is printed by Modern Printers. It is definitely recommended reading for all lovers of poetry. The Kilkenny Observer is happy to run the poems each week to promote creative writing and to highlight these wonderful centres. Available in all Kilkenny book shops. €10

There is, in all honesty, a Great Sadness within. Buddhists speak of Oneness. One morning, walking to work, a bullock in a trailer outside the butcher’s shop. His eyes met mine through a slit, reminded me of those trains; their eyes looking out. Saw myself in him, but that was only the beginning Ran into the chapel to escape people’s stare: kids on their way to school, deliverymen, shopkeepers. A woman crying in the street. Once inside, kneeling in a pew, this pain seeping through muscle, tissue and bone — a familiar pain.
On the walls, more suffering: images of a man humiliated, again and again — we do it so well.
Could not get this out of my head, cried incessantly, and later, beat the bed then buried it, again.
Janis Woodgate

Wrapped up neatly
Away from plain view, I hide my precious memories, true feelings and My love from you
In the past, once bitten,
Twice shy
Hesitant in sharing the softer side of myself with you, I display a tough exterior on view
White twine and an old suitcase, Each memory, true feelings and love
Wrapped carefully, metaphorically speaking, with white twine, Placed in an old suitcase, in my mind, Forever filed away,
Never to see the light of day, White twine and an old suitcase
Where the essence of me is destined to stay.
Mary Woods

We’re from part of the town knows as the Butts
They say to live here you got to be nuts
That’s always said from people afar
Sure they don’t know us or know who we are
We’re caring we’re passionate yes some of us loud
We know we’re great people and all of us proud
We’re sports men and women and we’re from the Butts
Put us out on the playing fields and we’ll show you guts
Like all great places there are one or two flaws
But they won’t deter us or prevent our cause
Most of the time we try to achieve
To set good examples for our youth to believe
A lot of the stories about us are wrong
Articles in papers that didn’t belong
Negative stories with a negative view
It’s really annoying when most are untrue
Some amazing families came from this place
We still hear the surnames or see that face
The Ramsbottoms, the Falseys, the Cliffords, the Doyles
The Dunphys, the Clowrys, the Rowes and the Boyles
The Murphys, the Phelans I could go on, the Dewberrys, the Hayes
Quigleys and Long
Singers and dancers some with degrees
Boys in bellbottoms and girls flashing knees
We’re creative we’re talented and we’re not ones to boast
To the people of the Butts it’s to you that we toast
As kids we were described as cheeky or pups
But now with all Ireland medals or McCalmont cups
There is nothing we can’t do when we stand side by side
Because we’re from the Butts and it fills us with pride
So if you’re from the Butts then let it be known
And remember our motto
LOOK AFTER YOUR OWN
Paul Clifford

William Carrigan will forever be synonymous with the Diocese of Ossory in which he served. On the 12th of December this year, we will see the 100th anniversary of his death and St Kieran’s College are hosting a conference to mark the occasion.
In recognising the anniversary of Canon Carrigan’s death, we aim to honour not only the man himself but also the enduring relevance of his work for
His meticulous attention to the intersection of Church , culture and history continues to resonate, offering a model for how local history contributes to our understanding of wider cultural and ecclesiastical dynamics.
In line with the conference title: ‘Carrigan: Church, Culture, Context’, this conference seeks to place Carrigan’s work within the ecclesiastical, cultural and
historical framework of his time.
Papers will explore how Carrigan’s scholarship was influenced by the intellectual movements of the late 19th and early 20th centuries, including the growing interest in antiquities, archives, the importance of the Church’s role in preserving cultural heritage, and the significance of local history itself in shaping our national identity.
Canon Carrigan’s life and work represents a critical juncture between the past and present in Irish historical scholarship.
As a priest and historian, he occupied a unique position where his ecclesial duties intertwined with scholarly inquiry, enabling him to capture the spiritual and material fabric of the Diocese of Ossory with an unparalleled depth.
His work remains one of the most comprehensive accounts of a dioces in Ireland, notable for its careful attention to detail , reliance on primary sources, and engagement with the architectural cultural and religious artefacts of the region.
The conference is scheduled to take place in St Kieran’s College on Friday 13th and Saturday 14th of December with a broad range of speakers already committed and more to follow.
It is hoped that the workings of this conference , and some associated papers will later be published.
Labour’s Councillor Seán Ó hArgáin in Kilkenny City and General Election candidate for Carlow/Kilkenny has responded with deep concern to the latest September housing figures, which reveal that 14,760 people are now in emergency accommodation nationwide, including a devastating 4,561 children.
Cllr. Ó hArgáin said,
“Here in Kilkenny and Carlow like everywhere in Ireland, we are hearing about the same heart-breaking stories: families forced into emergency accommodation, parents unable to find affordable housing, and children growing up without a stable home. Ireland is a wealthy nation, and the fact that 4,561 children are living in such precarious conditions is simply unforgivable. This government, led by Fianna Fáil and Fine Gael, has failed families across Ireland.
This, on the heels of two damning reports released this week: the Simon Community’s “Locked out of the Market” report and Threshold’s impact report on renters. Both reports have underscored the severity of Ireland’s housing crisis and highlighted the government’s continued failure to deliver on its promises.
“We’ve had report after
report laying bare the devastation caused by this government’s policies. This Government’s ‘Housing for All’ plan has failed by any metric. Homelessness figures are up, evictions are up, and house prices are up. And as I speak to people across Carlow and Kilkenny, housing is the issue that dominates
investment, not just in housing but in people’s futures.
“Fianna Fáil and Fine Gael have failed, plain and simple. We in Labour have a clear vision for housing. That means stronger protections for renters and significant investment in public housing. We believe in building better,




Prep: 20 mins
Cook: 3 hrs and 30 mins
Serves: 6
Master roast pork with crispy crackling using our easy recipe. This makes for a special Sunday lunch, served with roast potatoes and veg.
Ingredients
• pork shoulder joint
• vegetable oil
• fine sea salt
• onion, sliced
STEP 1
Heat the oven to 240C/220C fan/gas
9. Remove any packaging from the pork, retaining the string, and pat dry with kitchen paper – you want the skin to be as dry as possible. Score deep cuts into the skin in a diamond pattern using a sharp knife (you want to cut into the fat). If the skin is already scored, make sure each cut is dry and can be easily opened. Rub the oil into the skin, rubbing it well into each cut, then sprinkle the salt over in an even layer, rubbing this into the cuts, too.

STEP 2
Scatter the onion slices over the base of a large roasting tin and sit the pork joint on top. Roast for 2030 mins, or until the skin starts to blister and bubble. Put the kettle on to boil.
STEP 3
Pour half a kettle of boiling water
around the joint to cover the base of the tin, ensuring it doesn’t drip onto the skin. Reduce the oven temperature to 180C/160C fan/gas
4. Roast for another 2 hrs 30 mins, or until the meat under the skin is very tender when pressed. There’s a lot of fat in pork shoulder, so cooking at a low temperature this way ensures the meat doesn’t dry
out – if needed, it can cook for up to 3 hrs.
STEP 4
Turn the oven back up to 220C/200C fan/gas 7 and continue to roast the pork for 20-25 mins until the skin is very crisp and has started to harden – it should feel brittle when tapped with a knife.
If needed, cook for 10 mins more to achieve this. Remove the pork from the oven and rest for 20 mins in the tin, loosely covering with foil. Remove the crackling in large pieces, then break into smaller chunks. Carve the meat and serve alongside the crackling and your favourite sides.
Serve one or two of these per person for brunch - depending on how hungry/ greedy you are.
Prep: 10 mins
Cook: 20 mins
Serves: 2-4
Ingredients
• 1 tbsp white wine vinegar
• 4 of the freshest eggs you can get
• 300g spinach
• 25g butter, for frying and spreading
• 2 muffins, split
• 4 long slices good-quality smoked salmon
For the hollandaise sauce
• 2 egg yolks
• 140g butter, melted
• juice ½ lemon
• pinch cayenne pepper
Method
STEP 1
STEP 2
Heat a shallow pan of water with the vinegar but no salt until gently boiling, then poach the eggs for 2 mins. Remove with a slotted spoon and cool in cold water.
STEP 3
Fry the spinach in a wok with a knob of butter until wilted, then drain and season.
STEP 4
To serve, heat the grill to high. Lay the muffins on a flat roasting tray, cut-side up, then toast until brown. Butter the muffins lightly, then top each with a ruffle of smoked salmon. Divide the spinach between the muffins, leaving a slight dip in the middle to sit the eggs in. Spoon a quarter of the sauce over each egg, then return the tray under the grill to brown for a min. Serve immediately.
To make the hollandaise, sit a large bowl over a pan of hot water and whisk the egg yolks with 2 tbsp hot water. Gradually add the melted butter (without adding the milky liquid at the bottom) until it has all been incorporated. Whisk in the lemon juice and season with the cayenne pepper and salt to taste, then set aside.


Netflix is on a roll when it comes to new thriller movies. First, the streaming service dropped the excellent Rebel Ridge and then followed it with the even better Woman Of The Hour. Next up to the plate is Don’t Move, a survival thriller so intense that you might find yourself holding your breath.
From directors Adam Schindler and Brian Netto, and producer Sam Raimi, Don’t Move opens with a woman named Iris (Kelsey Asbille) taking a trip to a secluded forest. But she’s not here for a peaceful hike through the lush woodlands, she’s deep in grief after losing her young son several months previously.
In the woods, she meets a stranger, who introduces himself as Richard (Finn
Wittrock). At first, Richard seems friendly, but his sinister true intentions are soon revealed. He injects Iris with a paralytic agent, and she has just minutes before her entire body shuts down and she’s rendered immobile. What follows is a deadly game of cat and mouse as Iris attempts to escape her tormentor. But how do you evade a psychopathic killer when your limbs are frozen and the only thing you can control is your eyes? In this unthinkable nightmare scenario, Iris can hide but she can’t run.
The core narrative hook of Don’t Move is an intriguing one. In a typical survival thriller, the protagonist may not be able to outmuscle the deranged killer stalking them, but they can at least outrun, or outfox them. Iris
can’t do either. She has to survive her ordeal while being almost completely locked in place, which makes for some seriously intense sequences. This is where Don’t Move finds the greatest success. The tension is often so palatable that you might end up holding your breath out of pure terror. You can practically feel Iris’ burning frustration as she wills her limbs to move without success. It’s maddening, but also terrifying, and it’s these scenes, such as one where Iris flops into a rushing river to escape, that are the most memorable.
Unfortunately, even with a zippy runtime of 85 minutes (sans credits), there’s only so far this premise can stretch, and towards the end of the movie, Don’t Move
becomes a little too reliant on plot contrivances. How much movement Iris can muster also becomes a little inconsistent. However, these issues can be forgiven in the name of keeping the pacing up and the story moving forward.
Viewers craving a little blood are also well-catered to. To keep things interesting, a few additional characters are thrown into the mix (a helpful passerby and a curious cop), and in these moments the spotlight is taken off Iris and instead, we see Richard in full flow, using every trick in the psychopath playbook to cunningly convince these people to believe him. The results are brief but intense moments of violence that help raise the stakes even higher.
Marvel’s Agatha All Along is casting its spell on Disney+, but it’s not just about magic — it’s about breaking boundaries. In a pivotal moment, Agatha Harkness (Kathryn Hahn) reveals her queerness in the latest episode Death’s Hand In Mine, confirming fan theories and marking a major step for LGBTQ+ representation.
As she and Billy (Joe Locke) explore the Witch’s Road, her identity is subtly
affirmed, and fans couldn’t be more excited.
“Hey, you want straight answers, ask a straight lady,” Agatha tells Billy after he asked about the fate of his mother, Wanda.
Agatha’s reveal is a major win for queer representation in superhero media. Historically, such media has lacked LGBTQ+ characters, but this moment brings more inclusivity to the franchise. Fans celebrate as
Marvel embraces a beloved character’s identity, adding depth to the story and resonating with a diverse global audience.
Previous episodes dropped several hints about Agatha’s queerness, particularly during her close encounters with Rio (Aubrey Plaza). The tension between them was clear as they came close to kissing, exchanged stories about the marks they left on each other, and reflected




on their past, suggesting a deeper connection.
With Agatha All Along nearing its finale, fans are eager to see more LGBTQ+ stories in superhero movies. Agatha’s reveal opens the door for more inclusive narratives, and we’re excited to see how Marvel continues to evolve. Agatha Harkness has kicked off a new chapter, and it’s clear the future of queer storytelling is brighter than ever.

1. Escape at Dannemora
Ben Stiller is on fire right now thanks to his Apple TV+ series Severence (which just got a season 2 release date and trailer), but one of his other forays into TV came back in 2018 when he teamed up with Showtime for Escape At Dannemora.
At a correctional facility in northern New York State, a seamstress becomes enthralled with two inmates and helps them in their attempt to break out is the synopsis of the critically acclaimed eight-part miniseries. Given Prison Break is still topping the global charts right now, this is a great series to tackle next.
2. Territory
Sticking with another new series, we move onto Territory on Netflix, which has been compared to Succession mixed with Yellowstone, which sounds like a combination for a winner. Filmed in Australia, the plot surrounds the aftermath of a rich ranch owner passing away with nobody set to inherit his land, leading to an all-out war. It’s getting pretty good reviews from audiences thus far, and it currently holds a 7.0 on IMDb.
3. Nope
This thriller On Amazon Prime Video from July 2022 comes from director Jordan Peele follows a family of horse ranchers who provide animals for Hollywood productions. When things start falling from the sky and people go missing, OJ (Daniel Kaluuya) and his sister Em (Keke Palmer) hatch a plan to film the terrifying phenomenon and strike it rich.
4. Smile
After witnessing a bizarre, traumatic incident involving a patient, Dr Rose Cotter starts experiencing frightening occurrences that she can’t explain. As an overwhelming terror begins taking over her life, Rose must confront her troubling past in order to survive and escape her horrifying new reality. On Amazon Prime Video.
5. Horror In The High Desert
In July 2017, an experienced outdoor enthusiast vanished in Northern Nevada while on an outdoor excursion. After an extensive search, he was never located. On the three-year anniversary of his disappearance, friends and loved ones recall the events leading up to his vanishing, and for the first time, speak about the horrifying conclusion of his fate. On Amazon.

CLUB LOTTO
The Lotto results for 22nd October. Numbers drawn were 1, 21, 26. There was no Jackpot winner. Prize monies of €30 were awarded toeach of the following, Sadie Knox, Jimmy Dunne, Maisie Brennan, Donal McDonald, Padraic Brennan.
MINOR HURLING
Clara had a great 1-19 to 1-16 win over St. Martins on Monday night of last week in Tinryland in the final of the Central Hurling League.
U21S WIN
The Clara U21 hurlers progressed to the semifinal of this year’s championship by virtue of a 0-19 to 1-8 win over Carrickshock at a highly impressive newly revamped Hugginstown venue on Saturday afternoon. Plenty of rain fell on Saturday morning and a slippery surface and heavy ball made for difficult hurling conditions. It took Clara a long time to get motoring here and they will know themselves that much improvement will be needed before they face John Lockes of Callan in the next round.
The first half was very tight, after which Clara led 0-7 to 0-6, having played into the breeze. The scores had come from Conor Hoyne 0-4, Joe Power, Sean Carrigan and Davy Barcoe. Clara were the better side but a touch of casualness and some overelaboration had left the door open for Carrickshock.
Rory Glynn and Conor Hoyne from a free got Clara off to a bright second half start. Then after the ‘Shock had pulled one back from a free, Clara reeled off 7 in a row to break this contest wide open. The sequence was started by the very impressive Joe Power and Luke Lawlor and then Conor Hoyne hit five on the bounce, four of them from placed balls. Clara now had a nine point lead and were in total control but Carrickshock landed a goal to give them some hope. However this was short lived as Joe Power and Rory Glynn closed out the scoring to give Clara their final margin. Team - Conor Cody, Ben Crow, Zach Lawlor, Hugh Kelly. Ben Murphy, Harry Boyle, Luke Lawlor 0-1. Philip Carrigan, Ned Langton. Joe Power 0-3, Davy Barcoe 0-1, Sean Carrigan 0-1. Rory Glynn 0-2, Cian Kelly, Conor Hoyne 0-11, 0-8f. Subs used Daniel Ryan, Dillon Cummins, John Bergin, Jake Maher.
MEMORIAL MATCH
The James Nolan Memorial Match will take place on Saturday 2nd November at 1.15 pm in Clara GAA Grounds. The match will be between a selection from Clara GAA Club and Galway New York, whom James represented in 2014. We would like to invite all members of the community and GAA Club to attend.
O’LOUGHLIN GAELS
DISAPPOINTING DAY
Sunday 27th October proved to be a disappointing day for O’Loughlin Gaels supporters. The club’s camogie team travelled to Raharney in Westmeath in the morning to play the local team in the Leinster Club Intermediate Camogie Championship. Unfortunately the team lost out by 0-6 to 0-4.
Things didn’t get any better in the afternoon in UPMC Nowlan Park when the senior hurlers lost out to Thomastown in the St. Canice’s Credit Union Senior Hurling Championship final. In a game when the team never really got going the Thomastown side proved far better on the day. Congratulations to them on their win and all the best in the AIB Leinster Club Championship. Thanks go to all of the players and the Management teams for their time and effort representing the O’Loughlin Gaels club and to the supporters who followed both teams and flew our colours with pride around the parish.
BEIDH LÁ EILE.
World Handball Championships
The oneills.com World 4-Wall Handball Championships served off on Saturday last at the National Handball Centre in Croke Park and various Leinster venues including O’Loughlin Gaels with almost 1,700 entries from Ireland, the USA, Canada, Mexico and Japan.
O’Loughlin Gaels boast fantastic handball facilities including the state of the art court with a full glass back wall and comfortable seating for spectators. Great credit is due to the club’s handball chairman John Morrissey under whose direction a great deal of work has gone into preparing the handball facilities for the championships. They will be in use throughout the week from 9am to 9pm.
WELCOME GIFT
Many thanks from O’Loughlin Gaels to Stephen in SPSolutions, Hebron Industrial Estate for his gift of a desktop projector to the club. It will prove very useful for teams and presentations. CLUB LOTTO
There was no winner of O’Loughlin Gaels club lotto dated October 22nd. The numbers drawn were 4,14,16, 25 and Bonus 5. Play now at www.oloughlingaels.com/lotto Promotors Draw,1. Sheila Lyster c/o H Mahon. 2. Ml Doran. 3. Damien O’Connell. 4. Tommy Coyne c/o K Cleere. 5. David Goulding c/o D O’Driscoll. 6. Ann Loy c/o N Loy. 7. Eddie Kearns. 8. John Brennan c/o Online. 9. Ellen O’Brien c/o Online. 10. Ger Foley c/o Online NOTES
If you wish to have any item included in the St. John’s Parish notes please email it to pro.oloughlingaels.kilkenny@gaa.ie
FRESHFORD
CHAMPS Congratulations to St. Lachtains U14 boys who defeated Carrickshock in the U14 Roinn B shield final in a wind swept MW Dunmore on Sunday morning last. The boys had the wind behind them in the first half but struggled to use it to their advantage and went in at the break trailing 0-4 to 2-5. However, a determined second half performance saw the boys take the lead in the closing stages, which they held onto until the final whistle and finished winners on a score of. St Lachtains 3-7 Carrickshock 2-8. Well done to the boys and the management and backroom team on this victory.
JUNIOR COUNTY FINAL
All roads lead to Nowlan Park on Saturday next when St Lachtains take on Windgap in the Junior County Final at 2.30pm. Tickets will need to be purchased before the game. Keep an eye on our social media accounts for ticket details. So please put out your buntings and flags and go along in your colours and support the lads in their quest for glory on Saturday.
BOXING
On November 2nd and 3rd Freshford/Urlingford Boxing Club will be represented by four of their boxers at the upcoming Limerick open boxing cup. This is a prestigious competition as current All Ireland winners plus invited boxers will compete. Johnny Delaney goes in the 48kg category while Willie Delaney competes in the 34kg category with Edward Delaney taking part in the 57kg and Michael in the 38kg group. The Club would like to wish all the very best to their boxers and are very proud to be represented by them. November will continue to be a very busy month with the Clubs Leinster Development Squad rep Thomas Delaney travelling to Latvia to fight in the 67kg category from the 21st to 25th November. Training takes place every Tuesday and Thursday evening and new members are always welcome to attend.
HOME FROM AUSSIE
Home from down under at present in his native Threecastles is Seamus Hayes and his Dungiven born girlfriend. Seamus emigrated to Australia a number of years ago and is back regular. He was an ardent member of St. Lachtains GAA teams over the years since his schoolboy days and is still playing out in Australia.
He hopes to take in the Junior final on Sunday next and see his former team take the honours.
WED
Congratulations and best wishes go out to local hurling star Brian Kennedy and his new wife Michelle Graham who were married last week in St. Johns Church, Kilkenny with the reception being held in Langtons Hotel. They are wished all the very best in their newly married life together. Brian is a member of St. Lachtains Hurling side who are playing in the Junior County final on Saturday next at Nowlan Park.
SYMPATHY
Deepest sympathy is extended to Adrian and Maria Cahill, the parents of three year old Lillibet Cahill, late of Rathmoyle who died recently. Mass of the Angels took place in Tulla Church followed by burial in the adjoining cemetery.
BRIDGE
Bridge classes will commence in Tulla Hall on Monday 4th November from 7.30pm to 9.30pm for 10 weeks. Anyone interested in attending the classes should contact Mary on 087 2369535
SOCCER
Freshford town Junior side were defeated by Highview Athletic on Sunday morning last in their home league game coming out the wrong side of a 4-3 scoreline
Meanwhile in the schoolboys/girls section the U12 girls were beaten 3-2 by Newpark on Saturday with the Freshford goals coming from Kera Gibbons and Aubrey Walsh
The U16 boys went down 4-2 to Freebooters also on Saturday with Hugo Carroll and David Ryan scoring for Freshford side. The soccer academy for young boys 5/6 upwards continues each Saturday at 9.30am and will continue each week.
The Club is presently looking for volunteers across all levels and if you can help or give a bit of your time they would be most grateful. You can contact any member of the Committee or just turn up at the training sessions
IONAD LACHTAIN
St St.Lachtains Church Museum and Arts Centre. Is open Saturday and Sunday from 11.30am to 4.30pm. .
A wonderful first Ned Kennedy inaugural lecture was held in Ionad Lactain on Sunday afternoon last. With a good crowd in attendance Turtle Bunbury hosted the inaugural Ned Kennedy Memorial Lecture with a most engaging and informative lecture. It was held in honour of their late committee member and local historian Ned Kennedy and they will be hosting a special historical talk each year. This year historian Turtle Bunbury gave a talk on “The Irish Diaspora: Tale of Emigration, Exile and Imperialism”.
SPLIT THE POT
Last week’s winner of split the pot was Kathleen Doyle, Wood view winning €375. This month’s split the pot proceeds was in aid of Freshford Playground and thanks goes to all those who supported the cause which is a great addition to the village. Entry cost just €2 and envelopes are available in all local shops and pubs.
BINGO
The weekly bingo sessions continue each Friday evening in Freshford Community Hall at 8pm with some good prize money and a raffle each week. All proceeds goes to the Irish Wheelchair association. The Committee thank all the people who have turned up each week so far and ask you to please support this weekly fundraiser and tell your friends and spread the word around.
LOOP CAFE
Loop Community Café held a cake sale with special treats for the kids for Halloween on Saturday last. They are open each day from Monday to Saturday from 9.30am to 4pm. Platters of sandwiches are available for any occasion and they are looking for new pairs of hands to help out. Chopping vegetables, washing plates, cleaning counters, making coffee – you name it, we need it! If you can take part any time from Monday to Saturday, even for an hour or two, please stop by or call the café at 056 8832650
Winner of the beautiful painting by local artist Michael Cantwell was Billy Barnaville Kilkenny. Thanks to all those who supported the raffle.
KNIT AND KNATTER
Every Wednesday morning in the Loop Cafe there is a knit and knatter session from 10am to 11am. Fee is €6 per person which includes tea/coffee and sweet treat. No experience is necessary and guidance is given. New members are always welcome so why not go along and gain a new skill and more importantly have fun.
TRAD MUSIC
Lisdowney Traditional music group resumed recently and contin-

ues each week in Community Hall Lisdowney and continues each Thursday. Children from six upward are all welcome.
PARISH NEWS
Mass
is held in the Parish Church each Wednesday morning at 9.30am and each Sunday morning at 11am.wiith Mass in Tulla Church on Saturday evenings at 7.30pm. And 11am Maas in St. Lachtains Church on Sundays. The parish newsletter is available on their website every week and also on the website you are free to pay your dues and make donations or any other contributions and you can find out more about it on the website or feel free to contact in the Parish Office. Please note community notices for the parish newsletter should be left in or emailed to the Parish Office by 11am on Thursdays. Parish office hours are Tuesday, Thursday and Friday from 9am to 1pm. Mass Cards
Special printed parish cards are available at the Parish Office or from Annette at Tulla Church signed by Monsignor Kennedy. You can contact the Parish office on 056 8832843 or by email – freshfordd@ossory.ie. Contact Mongr Kieron Kennedy on that number or on 087 25235 21
HELP FOR ALL
Are you struggling with anxiety or depression or finding life difficult or feeling isolated at this time GROW is there to help you. Their Mental Health support Groups are free and confidential and open to all no referral or booking is needed. For more information on same you can contact Mary on 087 284342 If you can’t cope and need support text HELLO to 50808. SAMARITAN - Whatever you’re going through a Samaritan will face it with you – available 24 hours a day 365 days a year –Freephone 1161Alone is available for older people who need support and you can call them on 0818 222024 (8am to 8pm) AMBER KILKENNY WOMENS REFUGE – is available for confidential support relating to domestic violence - call them on 1850 424244 (24/7) or on 056 7771404 or email into@amberwomensrefuge.ie.
JAMES STEPHENS GAA AND CAMOGIE CLUB
U-21 HURLING CHAMPIONSHIP
At the end of the first 30 minutes of a fast paced, and keenly contested, U-21 “A” hurling semi-final between James Stephens and Young Irelands the home club took a somewhat flattering 1-09 to 0-06 lead into the break. This was largely due to a solid defence in which full back Adam O’Connor excelled with able assistance from his corner backs Stephen Power-Kellett and Dara Behan. Also frustrating a lively Young Irelands attack into a high rate of unsuccessful scoring attempts were half backs Noah Manogue, Oisin Bateman and Sam McEvoy while Sean Bergin and Eoin Deely provided solid back up to limit the Gowran club’s scoring potential. With the home team holding a 0-07 to 0-05 lead in the 27th minute an Ed Lauhoff solo run through the Young Irelands defence for Stephen Manogue to finish to the net proved a decisive score. Sean Deely and Stephen Manogue finished the half to give James Stephens the edge at 1-09 to 0-06. A Young Irelands surge of points in the first 10 minutes of the 2nd half narrowed the divide to 1-10 to 0-11 before Sean Deely (10 and 16mins), Ed McDermott (12mins), Noah Manogue (16mins) and Ed Lauhoff (13mins) revived the Village men’s cause. In the 19th minute Stephen Manogue whipped the sliothar to the net to extend the James Stephen’s lead at 2-15 to 0-11. A penalty award to Young Irelands in the 24th minute followed by a point only sparked the James Stephens attack into further action as they went on to finish the contest with points from substitute Paddy Keogh, Ed Lauhoff and a last-minute goal from Bill McDermott for a comprehensive victory.
CAMOGIE ALL-STAR
Congratulations to Hannah Scott on her selection at left half back on the 2024 Intermediate Camogie All-Star team on the back of outstanding performances for Kilkenny in their run to the All-Ireland Intermediate final which ended in a one point defeat to defending champions, Cork. The steely defender with the skill set to chip in with vital long range points for both club and county over the season is a worthy recipient of the national award. The St. Luke’s Hospital based podiatrist will be presented with her award at a Gala Night in Croke Park on Friday night 15th November. Well done Hannah.
DE FIB TRAINING
The Kilkenny County Board is holding a Defibrillator training course in Nowlan Park on Monday night, 4th November from 7 to 9.30pm. As places are limited, any club member interested in completing the training programme should contact the co-ordinator, Carmel Kenny at 087 6680084 or via email at chair. hwv.kilkenny@gaa.ie. Carmel advises that there is a form to be completed in advance of the meeting which she will forward to the applicant.
SYMPATHIES
At Wednesday night’s management meeting the sympathies of the club’s membership were extended to former club treasurer Tom Keane on the death of his brother John Keane, Carrigaline, Cork. From a family with a strong GAA heritage, John was a long standing member of the Carrigaline GAA club and a lifelong loyal supporter of the Rebel county. We extend our condolences to John’s wife Margaret, his daughter Triona, sons Conor and Daire, his sister Kathleen and brothers Ned, Dick and Joe and the extended Keane family. John was laid to rest in St. John’s Cemetery following Requiem Mass in Our Lady and St. John’s Church, Carrigaline on Monday afternoon. “Air dheis laimh Dei go raibh a anam dilis”
Last week’s numbers were 8, 14, 17, 20. There was no winner.
The €40 consolation winners were Jim Dollard, Breda Manogue, Veronica Robinson, Maggie Bourke and Ger/Marie/Ger. KILKENNY HORTICULTURAL SOCIETY
Kilkenny Horticultural Society will hold a garden lecture by renowned gardener Hestor Forde in the Club House Hotel on Wednesday November 6th at 7.30pm. Admission is €15. There will also be a plant sale on the evening. All are welcome.
BENNETTSBRIDGE
MENS SHED
Members of the Men’s Shed deviated from their usual activities last Wednesday when they organized a surprise celebration for Liam Cleere, who celebrated his ninetieth birthday on 22nd October. Some members of Liam’s family were present, including his wife Iris, son Gerry, daughter, Fiona, daughter-in-law, Karen and granddaughter, Róisin. A very enjoyable afternoon was had with birthday cake and other goodies. Thanks to the Men’s Shed for hosting the event.
A family get together is planned for November when other family members from overseas are looking forward to celebrating this special occasion.
Liam has a unique collection of hurling medals having played with Kilkenny Senior hurlers and Bennettsbridge Seniors. He played in a dual capacity for Kilkenny and Bennettsbridge, in goal and out the field.
He has an All Ireland Senior medal with Kilkenny in 1957. 3 Leinster Championships, ‘57,’58, 59. ( Outfield in 58/59 ) Played outfield in the 1960 Leinster Final which Wexford won. 2 Oireachtas titles, ‘57 and ‘59. ( ‘57 in goal and ‘59 outfield ). 5 Walsh Cups mid fifties. 10 Senior Hurling Championships with Bennettsbridge. One Minor Championship Medal with Disksboro 1952. In later years he acted as steward for KIlkenny County Board and at local level he holds the title of President of Bennettsbridge GAA, a position held jointly for many years with the late Johnny McGovern. Liam is wished many more happy years with his family and friends.
BENNETTSBRIDGE COMMUNITY AND TIDY TOWNS
Bennettsbridge Tidy Towns Group would like to wish Mary Hearn the very best of luck in the future. Mary has worked under the Leader Rural Development Scheme in Bennettsbridge for the past eight years. We would like to take this opportunity to thank Mary for all her hard work, she will be greatly missed by the Tidy Towns Group and Community alike. Going forward Bennettsbridge has no Scheme Workers appointed to the village.
TEMPORARY CLOSURE
A Temporary closure will apply to the car park across from the graveyard on Tuesday evening as Kilkenny County Council prepare for re-surfacing works and line marking to be carried out Wednesday, Thursday and Friday of this week. There will also be some work carried out on the tennis court behind the community Centre. Funding for these works was secured under the Community Recognition Fund. Safety improvement works will also be carried out on Main Street which will include the installation of a speed ramp to slow down traffic.
ART GROUP AND CHRISTMAS CARDS
The Christmas Card Project sponsored by the Bennettsbridge Art Group is now underway. Cards are available in the local outlets and feature all your favorite scenes with some new additions. The Art Group is delighted to be involved in this initiative which promotes Bennettsbridge overseas at this special time of the year. Thanks to the local shops who continue to stock the cards and as usual the St Vincent De Paul will share in the proceeds.
Advance notice of our Christmas Art Fest to be held on Sunday, 8th December from 11 am to 5pm. Opportunity to pick up some special presents for loved ones. Craft decorations, textile hangings, Christmas Cards and some hand-knitted mittens (big hit last year).
CHURCH NEWS
Ft Pat Duggan celebrated a special mass recently for deceased members of the Men’s Shed.
Masses during the week, Tuesday evening 7,30pm, Wednesday and Friday morning, 10.30am Saturday(Tullaherin) 8pm Sunday(Bennettsbridge) 10.30am.
NOVEMBER OFFERINGS
Thanks to all who subscribed to the October Stations. The November offerings will be due this month. Masses for the deceased will be offered during the month of November. The names of deceased family members can be listed on the leaflet in the envelope.
BLESSING OF GRAVEYARD EXTENSION

Bishop Niall Coll will bless the Bennettsbridge graveyard extension on Sunday, 8th December after 10.30am mass.
SYMPATHY
Sympathy is extended to the Mulcair family on the death of Jimmy Mulcair, College Road, Kilkenny and formerly from Woollengrange, Bennettsbridge. Jimmy was well known in the business community in Kilkenny where he ran a very successful Jewelry Shop for a long number of years.
CARD RESULTS
8th October. First Prize, Brian Blackmore/Annie Lehane,(12 games)Second Prize,Tom Drennan/Jack Bolger, Richie Proctor/ Brenda Malone, Joan O’Gorman/Siobhán Donovan ( 10 Games ). Table Prize, Nicky Fitzpatrick/Lar Gibbons 15th October, First Prize, Pat Savage/Brian Ireland ( 11 games ). Second Prize, Brendan and Eugene Malone. Mary Doyle/Mary Cummins, Jack Kavanagh/Pat O’Neill ( 10 games ). Table Prize Nicky Fitzpatrick/Michael Kenneally 22nd October. First Prize Vinnie Horgan/Andy Barcoe, Michael Kenneally/Neddie Walsh, Bridget Murphy/Tommy Hayes, Pat Savage/Toddy Skehan ( 11 games ). Table Prize Ger O’Neill/Jack Kavanagh.
LOTTO
No winner of Jackpot, Numbers, 6, 7, 11, 22. Consolation Prizes, Paddy Walsh, ℅ Butcher’s, Kay Cody, Stroan, Clare Wafer, Kilfane, Julie, Drennan, Coolmeen, BB Syndicate.
GATHERING
Birdie Moran was given a surprise Birthday Party on Wednesday last by her friends in the Gathering Group. Birdie is a popular member of the group and celebrated a significant birthday on the day. Afterwards the usual activities were enjoyed including gentle chair exercises, bingo and rings.
HANDBALL
Kilfane Handball Club are co-hosting the 2024 World 4-Wall Championships. The games started on Saturday 26th October. The Finals are in Croke Park alley on Sunday 3rd November. The Adults are in Kifane Fri 1 Nov. Sat 2 Nov. All are welcome.
CAMOGIE
Congratulations to Bennettsbridge Camogie Club who won the Junior B County Final on Saturday last defeating Blacks and Whites Camogie Club
BÓRD NA N-ÓG
The U12s finished their season last Thursday, they came up short against Danesfort in the Lights tournament Shield final.
The boys have had a great season playing 37 games. We wish the boys moving up to U14 the very best of luck. Thanks to Alan and Ambrose for all their work throughout the year. Enjoy the break.
EAST END UNITED
East End U14s had a great win in the SFAI National Cup 2nd round beating De La Salle 4-0 Congratulations to team and management.
East End U10s Girls showed off some great soccer skills playing
Evergreen well done everyone!
GAA



Under 21 Hurling
Well done to our under 21 team who had a fine win over Mooncoin in the quarter final of the Roinn A hurling championship in Mooncoin under lights last Friday night. The Bridge had use of a stiff breeze in the first half and built up a five point lead at half time. They stretched the lead in the second half but credit to Mooncoin who fought their way back into the match. However the Bridge lads finished out the game as victors on a scoreline of 1-17 to 1-15. Well done to all the players and management.
Lucky Dip Raffle
The senior players are running a fundraiser at the moment.
Tickets cost 1 cent to 20 euro in a lucky dip, for example a ticket pulled could cost you one cent or up to 20 euro maximum. Prize money is 1000 euro first prize, 500 euro second prize, 300 euro third and 200 euro fourth prize. Please contact Michael Shiel on 0868856810 or David Blanchfield on 0860529386 if you would like to take part.
Split the Pot
Well done to Siobhan Ryan who won 147 euro, Rosie Ryan who won 30 euro and Kevin Blanchfield who won 20 euro.Thanks again for the continued support.
O’Neill’s Club Shop

A new range has been added to the Bennettsbridge on-line shop on the O’Neill’s website Simply enter Bennettsbridge into the search box to access the full range of adult and kids club gear. A great gift idea with Christmas on the way.
GRAIGUENAMANAGH
GRAIG NOTES
Should you wish to submit news items, club events, announcements etc, you can do so by emailing them to graignotes@ outlook.com
LOTTO GAA AND SOCCER
The numbers drawn on 21/10/24 were 21, 10, 20, 24 there was no winner. The following Received €30 each Adam Sweeney, Laura Phelan ,Vincent Foley, Shirley, Cian Millie, Tickets are available from any club member.
GRAIG TIDY TOWN DRAW
The winners of the draw which took place on 24/10/ 2024. were First Prize Ciaran Dreelan €415.00, Second Prize € 50 Jim Brennan, and third Prize €25 Aoibhinn Canning. The following four won 25 euros each, Sarah Curran, Pat and Brid ,Walter and Breda, Brid and Pat. Money raised through Tidy Towns Jackpot will be used to keep the town looking well all year round. Draw takes place at 4pm on Thursdays.
RAMBLING HOUSE
The Monthly Rambling House Session takes place on the second Friday of every month in Newtown Hall, where you can enjoy music and song from local artists and also from many from the surrounding district also. The next Session is on Friday November 8th at 8.00pm.
MASS TIMES FOR DUISKE ABBEY GRAIGUENAMANAGH Monday to Friday 10 AM, Saturday 7,30 PM, And Sunday 11AM. CLINIC
Cllr. Peter “Chap” Cleere will hold his clinic on Monday Evenings from 7pm at his office in Main Street Graiguenamanagh.
GORESBRIDGE AND PAULSTOWN

BADMINTON An exploratory meeting to consider setting up a club will take place in Ionad Dara at 7pm on Thursday 7th November.
BRIDGE
and at 10.00am on Sunday as well as in Paulstown at 11.30am.
Weekday mass is at 10am in Paulstown this Friday and the following Tuesday and Thursday. Adoration of the Blessed Sacrament takes place in Paulstown every Tuesday after morning mass and lasts until 6pm.
FORÓIGE YOUTH CLUB (PAULSTOWN)
New members always welcome (aged 12-17) as well as volunteers. Contact Aidan Gleeson tel. 086 067 4485.
GATHERINGS
Weekly gatherings resume on Friday 11 October at 8pm. Contact Trish 086 3347 426
NATURE’S WAY (BORRIS AND GORESBRIDGE AREAS)
A pre-school and after-school service operates from 8.30am to 6pm daily at Scoil Bhríde in Goresbridge from this week onwards. Information: Ann O’Kelly (085 752 9485) or Michelle Cummins (089 947 3317).
TAR ISTEACH SHOP
Tar Isteach Shop is looking for mugs, dishes, cutlery, pots, pans, water glasses, pictures, vases, winter dresses, knits, if you are doing a clear out, we are also back taking ladies clothes, if you are planning a new wardrobe and want to get rid of winter clothes. We’ll take handbags, belts, scarves.
DICKSBORO
CLUB LOTTO
Dicksboro GAA Club LOTTO Results 24th October 2024, Nos: 6 7 19 30. The Jackpot was not won. Draw Prizes, €50: Deirdre Power c/o Online. €25 each Jason Dempsey c/o Online €25 each Steve Rochford c/o Online. €25 each Jim Manning c/o Jimmy Murphy. Hurlers Co Op Orla Morrissey c/o Ian Morrissey. Promotors prize Stella Doyle.
ADULT CAMOGIE
Hard luck to our Senior Camogie and Junior Camogie teams recently in their Championship Games. Last Sunday in UPMC Nowlan Park our Seniors took on Piltown in the County Final but it wasn’t to be our day. These bunch of girls are a credit to our Club who have given us a lifetime of memories and we thank them and their Management Team for their dedication and commitment. Congratulations to Piltown and we wish them all the best in their Leinster Championship Campaign. Our Junior Camogie team bowed out of the Championship in the Quarter Final against a strong Tullogher side. The girls have had a great campaign this year and we’ll see them all back stronger next year.
U21 CHAMPIONSHIP
Our u21 Hurling Team start their Championship campaign Saturday 2nd November at 11am in St John’s Park. They will play neighbours O’Loughlin Gaels in the Quarter Final. Best of luck to all involved.
HANDBALL
Well done to our underage Hurlers Rian Dowling and Ciaran Treacy who both won Leinster Titles in Wexford recently representing CBS Kilkenny CONGRATULATIONS
Massive Congratulations to our Senior Camogie Player Jenny Clifford & her partner Darragh on the birth of their beautiful baby boy Harry.
JOHNSTOWN.
CHURCH NOTES
First Communion Johnstown/Crosspatrick Saturday May 3rd 2025 at 11am.
Remembrance Mass for those from the parish who died during the year on Friday November 29th at 7.30pm. October Stations are due now.
Rosary will be recited in Johnstown Cemetery each Sunday during November at 2.30pm.
BRIDGE CLASSES
Beginning Monday November. 4th in Tulla Hall, Threecastles from 7.30 to 9.30pm for 10 weeks. Contact Mary on 0872369535.
LIBRARY
Flower arranging classes with Eva Holmes on November 6th and 13th. Call 0567794182.
CHILDRENS’ DISCO
A Childrens Disco is being held in the Community Hall on Sunday Nov 3rd from 5 to 7pm for children 14 and under. Donation € 3 D.J. Disco, face painting, nail art and treats. Wear your scary Halloween costumes.
KILKENNY LEADER PARTNERSHIP
“Minding your Mental Health” information session in the Library, Urlingford on Tuesday Nov 12th from 10 to 12noon. Contact Sarah on 0860843446.
JOHNSTOWN COMMUNITY HALL
A large crowd attended the screening of the “Pride of Place” video, and many who were there gave very favourable feedback on the renovations carried out on the Hall during the past year. The next part of the project involves the refurbishment of the seats on the balcony. Many older people spoke fondly of the films shown there many years ago and hopefully will be shown again when the balcony is completed. To this end Kilkenny Co.Co has granted the committee € 15,000 but the work will cost € 30,000, so to meet the shortfall, it is the plan to get each seat sponsored by an individual,family, group or members of the Diaspora. A sponsor name will be allotted to each seat. Closing date for same November 29th and contact can be made with Marie Garrett 0851880202, Fiona Sullivan 0879143574, Breda Campion 0863348462, Kevin Murphy 0868101378 or Bernie Fitpatrick 0868511190.
SPA UNITED AFC Weekend results U16 girls league division 1 Thomastown 2 Spa 1, U15 girls league division 1 Spa 4 Callan 1, U14 girls league division 1A Lions 3 Spa 1, U12 girls league division 1A Spa 2 Thomastown 1. U16 boys league division 2 Thomastown 0 Spa 4, U12 boys league division 2A Thomastown 2 Spa 0. The U10 boys took on Freshford in their development games . SPA DEVELOPMENT/FENIANS LOTTO The winning numbers for this week’s draw were 3,10,23,30, two match threes Kevin Power and Ann Ryan. Well done Ann and Kevin.
MILL FAMILY RESOURCE CENTRE
ST KIERAN’S HOMES FOR THE ELDERLY
Applications are invited for the Vacant Tenancy of a one-bedroom house at St Kieran’s Place, Urlingford. To be eligible to apply you must be on the Kilkenny County Council Housing list. Applications are available from the Centre.
LOCAL TRAINING PROGRAMME L.T.I.
Free L.T.I. Course, which includes Safe Pass, Manual Handling, Driving Theory/Driving lessons and much more. Places still available. Contact the Centre for further information.
COIS NORE
Outreach Advice Clinic, at the Mill every Friday Morning from 10am to 12pm
COUNSELLING SERVICES
Our low cost Counselling Services, includes One-to-One, Adult and Teens. General Counselling: Bereavement, Stress, Anxiety and Depression. Other Counselling Services available: Drug, Substance and Gambling Addictions. Play therapy is now also available. Age 4+. Please contact Sue for more information or to make an appointment.
SENIOR ALERT
If you need to apply for a Personal Alarm, please contact Sue or Josephine.
DEFIBRILLATOR
There is a defibrillator located in the Mill FRC if and when it may be required.
APPEAL FOR CLOTHES DONATIONS
Any clothes donations would be greatly appreciated in aid of our counselling/Play Therapy Services. Donations can be dropped off during our opening hours. Please call before dropping off.
YOUTH CLUB;
A Youth Club is held every Wednesday evening 5pm to 6.30pm. 8 years and upwards.
URLINGFORD
EMERALDS URLINGFORD AND GRAINE LOTTO
The Lotto took place on October 21th Numbers drawn: 11, 14, 25, 26, bonus no 3. Two match 3 winners: Canice Sweeney, Nora Neary. Five lucky dips of €20 each: Dan Norton, Ronan Guilfoyle, James Neary, Bridget Grace, Paul M. Minogue.
SET DANCING
In Graine Hall every Tuesday at 8.30pm. Music by Danny Webster. Sets called by Paddy Norton. New members welcome, young and old.
URLINGFORD ARMS SPLIT THE POT
The October 27th winner of Split the Pot is John Corbett who received €472. Congrats on behalf of Urlingford Community Hall Committee. Tickets €2 on sale in participating businesses in town or Revolut @urlingfordtt. Thanks to everyone for their continued support.
Next week’s draw is for Urlingford Community Hall.
GRAINE CARDS
Progressive 25 card game in Graine Hall every Wednesday night at 8.30pm sharp. All are welcome.
COIS NORE CANCER SUPPORT CENTRE
Has the Outreach Service available to the community of Urlingford and the surrounding areas every Friday morning. Call in for a chat, support, and registration to The Cois Nore Cancer Support Centre in Kilkenny. The Cois Nore Outreach service will be held at the Mill Family resource Centre from 10am to 12pm. Contact 087-4833941.
URLINGFORD / GRAINE DEFIBRILLATOR GROUP
In case of emergency, call: 085 2726396.
URLINGFORD NEWS
Anyone wishing to submit news items, club events, announcements etc., can do so by emailing urlingfordnotes@gmail.com. If you have any photos you wish to include, please forward them to the email address.
GORTNAHOE GLENGOOL
EUCHARISTIC ADORATION
Glengoole Wednesday 10am to 2pm, Gortnahoe Thursday 10am to 1pm. The rosary is recited before Mass in Glengoole every Saturday evening.
SACRAMENTAL DATES
The dates have been announced for the following sacraments in the parish. Confirmation will take place on Friday 28th February 2025 at 11am and First Holy Communion will be held on Saturday 17th May 2025 at 11am.
THANKS
Grace Campion thanks all who helped and contributed to the table quiz in Mary Willies in aid of her trip to Kolkata with Specsavers and the Hope Foundation to provide much needed eye care to disadvantaged communities. €2,000 was raised.
CAMOGIE CLUB
Gortnahoe Glengoole Camogie Club are holding a cookery demonstration by Naomi Morrissey of Naomi’s Cafe in Gortnahoe Hall on Friday 15th November at 7.30pm. Tickets €25.
400 CLUB DRAW
A sincere thanks to everyone who supported the 400 club draw in support of the Gortnahoe Glengoole parish. The new draw will commence in November and promoters will be contacting all households in the parish to renew their membership for the next 12 months. We look forward to the continued support of our parish.
GORTNAHOE COMMUNITY HALL CHRISTMAS DRAW
Gortnahoe Community Hall are holding their Christmas draw on Sunday 22nd December in Gortnahoe Hall. Further details of prizes and the distribution of tickets will follow in the coming weeks. The Christmas Draw is an important fundraiser for the upkeep of the Community Hall
GORTNAHOE BINGO
Bingo continues this Saturday evening at the earlier time of 4.00pm with doors opening from 3.00pm and will continue each
Saturday evening at the same time. Over €2,660 in prize money on offer including a special €500 game.
TUESDAY BRIDGE
Bridge is being played each Tuesday night in Gortnahoe Hall at 7.30pm. If you would like to join or find out more information please contact this number 089 4349106
SPLIT THE POT
Congratulations to Helen Morris, Ballysloe who won €180 in the Split the Pot draw last Sunday. Envelopes are available in Cahill’s Gortnahoe, Hogans Grange and at the usual outlets, you can also Revolut to 0876777220. For the month of November Split the Pot will be in support of the Gortnahoe Christmas lights. The draw takes place each Sunday at 12pm in Gortnahoe Hall. Your support would be appreciated.
SEAN DUNNE RIP
The death has occurred of Seán Dunne, Dublin 9 and formerly The Glebe, Fennor, Gortnahoe, October 20th, peacefully in the presence of his loving daughters Sharon and Jayne. Predeceased by his parents Michael and Bridget, his brothers Joseph, Michael and Noel and sisters Mary and Carmel. Sadly missed and lovingly remembered by his daughters Sharon and Jayne, their mam Valerie, grandchildren Heather, Evan, Jack, Kerrie and Saphra, sonsin-law Allen and Enda, brothers Seamus,Brendan and Eugene, sisters Eileen, Kathleen and Claire, brothers-in-law, sisters-in-law, nieces, nephews, extended family and a close circle of friends. Sean reposed at Doyle’s Funeral Home, Urlingford, last Tuesday evening. Removal took place to the Church of the Sacred Heart, Gortnahoe for Requiem Mass. Interment took place afterwards in Fennor Cemetery. May he rest in peace.
MARY BOWE RIP
The death has occurred of Mary Bowe, (Née Byrne) Boulick, Gortnahoe, October 20th, peacefully in the presence of her family at Fennor Hill Care Facility Urlingford in her 99th.Year. Predeceased by her husband Ned, son Paddy, daughter Geraldine, sisters Margaret and Ellen and brother Tommy. Sadly missed and lovingly remembered by her family, Josephine, Tommy, Marian, Michael, Pierce and Eamonn(twins), Martina and Gerry, sonsin-law, daughters-in-law, grandchildren, great-grandchildren, nieces, nephews, extended family, neighbours and a wide circle of friends. Mary reposed at Doyle’s Funeral Home, Urlingford last Wednesday evening. Removal took place to the Church of the Sacred Heart, Gortnahoe for Requiem mass. Interment took place afterwards in the Good Shepherd Cemetery. May she rest in peace
MARY BUTLER RIP
The death has occurred of Mary (Madie) Butler (nee Moore), Lisduff, Urlingford, October 22nd, peacefully surrounded by her loving family. Predeceased by her parents, brother Paddy-Joe and twin sister Julia. Sadly missed and lovingly remembered by her loving husband Eddie, sons P.J. and Eamon, daughters-in-law Martina and Cathriona, grandchildren Shay, his wife Chloe, Mark, David, Rachel and Adam, great grandchildren Ógie and Ayda, brothers Frank and Michael, brother-in-law John-Joe, sister-inlaw Pidge, nieces, nephews, extended family, neighbours and a wide circle of friends. Madie reposed at Doyle’s Funeral Home, Urlingford. Removal took place to St. Patrick’s Church Graine, for Requiem Mass. Interment took place afterwards in the adjoining Cemetery. May she rest in peace.
CONAHY
FOOTBALL
The intermediate footballers, having captured the county title earlier this year, will face novel opposition in Barcelona Gaels in the opening round of the Leinster Junior Club Football Championship on Saturday next at 12.00 in UPMC Nowlan Park. Best of luck to all involved.
CAMOGIE
The junior camogie girls had a busy weekend of action, firstly facing off Mooncoin on Friday evening last in Heywood C.S in the Cup quarter-final, and following victory in that game, playing host to Danesfort in the Cup semi-final in Jenkinstown on Sunday morning last.
It was a dramatic one point win for Conahy against Mooncoin, winning by 3-9 to 1-14. It was an equally tough and tight game against Danesfort. A second half goal helped Conahy open up a four point lead, but Danesfort fought back to level the scores at 1-7 to 0-10 with minutes to play. However, two late points from Siofraidh Kennedy and Grace Mulhall saw Conahy win out by 1-9 to 0-10.
Conahy will now face Windgap in the county final on Sunday morning next at 11.00 a.m. The venue is to be confirmed at the time of writing. Best of luck to all involved.
TEAM: Niamh Delaney, Aoife Gamble, Gráinne Comerford, Sarah Webster, Amy Lawless, Amy Morrissey, Hannah Murphy, Aisling Maher, Evelyn Phelan, Siofraidh Kennedy, Grace Mulhall, Aisling Downey, Molly O’Dornan, Robyn Morrissey, Emma Cahill, Emily Murphy, Sarah Molloy, Aislin Comerford, Naomi Kerr, Lauren Buggy, Molly Trait, Megan Hurley, Aisling Lawless.
CLUB LOTTO
The numbers drawn in the most recent GAA Club Lotto were 8, 14 and 35. There was no winner, so the consolation prize winners were Annette Healy, Marie Hogan, Michael Hestor, John and Margaret Bergin and Marguerite Waters. The promoter prize winners were Peter Mulhall, Helen Cahill and Nora Delaney. This week’s jackpot now increases to €1,400. Many thanks to everyone who supports the GAA Club Lotto.
SUNDAY NIGHT CARDS
Progressive 25’s take place every Sunday night in the GAA Clubhouse at 8.00 p.m. All are welcome.
NOVEMBER - MONTH OF THE HOLY SOULS
Mass to mark the start of the month of the Holy Souls will take place in Conahy Church on Friday morning (November 1st) at 11.30 a.m.
Parishioners are also asked to note that Sunday Mass in Conahy Church will be at 11.00 a.m. from this Sunday, November 3rd. Additionally, there will be the blessing of the graves in Conahy Cemetery for the month of November on this Sunday, November 3rd.
ST. VINCENT DE PAUL
Please note that the Conahy conference of the St. Vincent de Paul Society has a new contact number - (085) 2160466 - should anyone in the locality wish to avail of their support.
CONAHY BOOK CLUB
The Conahy Book Club is flying along in recent times. Books read this year include Lessons in Chemistry, Year of the Locust, A Thread of Violence, The Lost Dressmaker of Paris, Hannah Coulter, to name but a few. The Club don’t just read books, they listen to audiobooks too. So if you like to read or listen to books, why not join them for their Christmas night (they know it’s early) on Friday, November 22nd at 7.00 p.m. at The Orchard, Kilkenny, they would love to see you. The next book is “All the Colours of the Dark” by Chris Whittaker. If you would like to join the book club app, please text Marion O’Dornan on 087-1649567. COIS NORE CANCER SUPPORT
Cois Nore Cancer Support Centre Kilkenny have an Outreach Service for the community of Ballyragget and the surrounding areas every Monday morning. Call in for a chat, support, and registration to The Cois Nore Cancer Support Centre in Kilkenny. The Cois Nore Outreach service will be held in the morning from 10 am to 12 pm at Dr Hogan’s Rooms, The Square in Ballyragget. Please do not hesitate to drop or, for an appointment contact 087-4833941. Cois Nore Outreach is also available in Castlecomer on Monday mornings at The Old Courthouse, Kilkenny Street, Castlecomer from 10 am to 12pm.
BRIDGE CLASSES
Bridge Classes will commence at Tulla Hall, Threecastles on next Monday, November 4th, commencing at 7.30 p .m. to 9.30 p.m. for 10 weeks. If interested in attending the classes please contact Mary on 087-2369535.
HUGGINSTOWN NEWMARKET AND STONEYFORD
MASS TIMES
Aghaviller Parish, Hugginstown: Monday, Tuesday, Wednesday at 9.30a.m. Vigil, Friday 1st. at 10.00a.m. Vigil – Saturday 2nd. at 8.00p.m. Sunday 3rd. at 10.00a.m. Stoneyford, Vigil - Saturday 2nd. at 6.30p.m. Friday 1st. Feast of All Saints, Holy Day, First Friday Visitation with Holy Communion will take place as usual on Friday. Please let us know if you would like to receive Holy Communion in your home for the First Fridays or at any other time. Saturday 2nd. Feast of All Soules. Remembrance Masses for the Faithful Departed. Remembrance Masses for the Faithful Departed will be celebrated on next Saturday 2nd November in Stoneyford Church at 6.30p.m. and in Hugginstown Church at 8.00p.m. We will remember all who have lost a family member during the past twelve months. Families will be invited to bring a candle to the altar in remembrance of their loved ones during Mass.
If you had a family member who died outside the parish and would like them included in this Remembrance Mass, please let us know during the week. All are invited to write down the names of their own departed ones and place them at the altar. They will be remembered at all Masses during November.
PRAY FOR
Anniversary Masses, Eileen Henebery, Mylerstown, Mass in Hugginstown Church on Sunday 3rd. November at 10.00a.m. PARISH CONTRIBUTIONS
Many thanks to all who have contributed to the “October Station” Contributions during the past weeks.
ROTA
November 31st. (Sunday in Ordinary Time) Readers. Stoneyford, Saturday 6.30p.m. Margaret Ryan. Hugginstown: Saturday 8.00p.m. Valerie Farrell. Sunday 10.00a.m. Mary Carroll. Eucharistic Ministers. Stoneyford: Saturday 6.30p.m. Barbara Smolen. Hugginstown, Saturday 8.00p.m. Mary Murphy; Sunday 10.00a.m. Ruth Crowley
SAFEGUARDING CONTACTS
Diocesan Designated Liaison Person: Ms. Ailish Higgins Tel: 087 100 0232. Aghaviller Parish Representatives are: Deirdre Rohan and Catherina Roche.
LOTTO
Aghaviller Parish and Carrickshock G. A. A. Draw: Monday 21st. October 2024. Numbers: 31; 22; 18; 21. No Winner First 3 Numbers Drawn. No Jackpot Winner: €30.00. Winners. Deirdre Irish, Hugginstown: Ann, Suzanne, Stephanie Power, Lawcus. Chris Grace, Lismatigue, P. and C. Hudson, c/o James Irish, Aoife O’Neill, Dunnmaggin. 3 x €15.00 (Sellers) Teresa Fitzgerald, Jimmy Sheehan, Claire Cleary.
MASS OF REMEMBRANCE
Suir Engineering will celebrate Mass for our Deceased Colleagues on Friday 8th. November in the Church of the Assumption in Mooncoin, Co Kilkenny at 6.30pm. Followed by refreshments upstairs in Mooncoin G.A.A. Complex. All are welcome to attend.
Scripture – New Testament
Learning more about what it is that we believe. Course on 4th./11th./18th./25th. November in St. Kieran’s College. “Scripture - New Testament” given by Fr Fergus Farrell: • Approaching the Bible: The Word of God in Human Words.
• Introduction to the Gospels: Meeting Matthew. • One Jesus, Many Portraits: Jesus in Matthew and the other Gospels. • Paul and the Good News of Christ Crucified.
OLDER PEOPLES INFORMATION SERVICE; Kilkenny Older Peoples Council has arranged a series of information presentations, to be professionally provided, for people aged 55 and over, in the Mayfair Library, Parliament Street, Kilkenny. The Presentation given by An Garda Síochána on “Community Safety” on Friday 1st. November. Time 11.00a.m. to 1.00p.m. There will be plenty of time for questions and answers and a cup of tea. Booking is not required. When there, why not avail of an opportunity to see the new modern Library facilities that Kilkenny has to offer? All are welcome.

The Ireland Ladies Rugby Team have been enjoying a renaissance recently with victories against Australia and New Zealand, and part of the backroom set-up is Kilkenny man Tadhg O'Carroll.
Tadhg is Physiotherapist to the Irish Team, and his arrival has coincided with a revival in the fortunes of the International Team.
Ireland defeated Australia 36-10 in an International match played in Belfast to mark the 150th anniversary of the founding of the IRF U, and shortly afterwards they defeated New Z ealand 29-27 in Vancouver in a Womens International Tournament while another vict ory followed against USA.
The Irish Ladies have climbed up he world rankings from 11th to 6th following recent results,
BY PAUL BOLGER

We are so malleable when we are young. We soak up everything around us. While we can all learn and adapt throughout life, babies and children tend to soak up experiences at a supercharged rate. This helped our ancestors to survive – the faster that young children learn about the world around them, the better chance they have of survival.
Researchers are learning more and more about the impacts of childhood experience on lifelong health. One group of researchers in the UK, who have been following the life experiences of over 150,000 people, have shown that significant childhood maltreatment increases the rates of longterm health conditions much later in life.
Maltreatment
Now, maltreatment does not mean that a child was not given their way, or that their caregiver was occasionally too tired to give them their full attention. These researchers identified 4 types of maltreatment –physical abuse, sexual abuse, emotional abuse
and exciting times lie ahead for the Irish Team with a Rugby World Cup to look forward to next year in 2025.
Prior to returning to Ireland, Tadhg spent 3 years in Scotland working with Scottish Football L eague outfits Ross County and Dunfermline, as Ross County were plying their trade in the Scottish Premier League playing against Celtic and Rangers. Tadhg played with Kilkenny Rugby Club with their Juvenile Teams, with his Dad Billy centrally involved within the Rugby Club over the years. Away from his physio committments, Tadhg is a very enthusiastic mountain climber and back in 2012 while a student in Clongowes College in Kildare, he c limbed Mount Kilimanjaro the highest moun -
tain in Africa as part of a j oint fund-raising venture for Our Lady’s Hospital for Sick Children, Crumlin, and The Chernobyl Child rens Fund.
T he draw for next years Rugby World Cup was made recently on The One Show on BBC1, and Ire land have been drawn in P ool C with New Zealand, Japan and Spain. Ireland have beaten those three countries in recent times, and with the team on an upward trajectory they can look forward to 2025 with plenty of optimism. They will begin 2025 with a home game against France in the Six Nations next March, while fol lowing the conclusion of the S ix Nations they will turn their attention to the World Cup that starts in August. It could be a busy

can have a profound effect on health decades later

and neglect.
Maltreatment in childhood was common in this study – with 1-in-3 reporting at least 1 form of maltreatment.
Long-term conditions
The health conditions identified in this study were wide-ranging –including conditions such as heart disease, mental health disorders and pain. These researchers are smart, they are aware that it is common for people who have suffered from trauma in childhood to adopt unhealthy coping strategies or struggle in some aspects of life. They were able to adjust for these variables (like smoking, alcohol use, education level, etc.) to isolate the relationship between childhood maltreatment and health in adult life.
Long-term effects
Childhood maltreatment was found to be associated with a greater risk of adult health problems. Longer duration of maltreatment and a greater number of different types of maltreatment put people at an even higher risk of suffering from a greater number of health issues as adults.
Now, this does not mean that suffering from maltreatment guaranteed
print, the Republic hoping to have qualidown against either Wales
Molloy recently recalled to the Irish Squad following
If the Irish Ladies Soccerros, Kilkenny can expect to ave strong representation in both Soccer and Rugby - all going well - in what
somebody future health problems. Just like how smoking doesn’t guarantee lung disease, and not smoking doesn’t protect fully from it. Life is complex – so many factors play a role in our health. However, we can be confident in saying that childhood maltreatment increases the risk of longterm health conditions. How exactly it plays a role, we will explore next week.
Protection from harm Some people may come through a highly traumatic childhood and lead quite healthy and long lives. What allows some people to thrive while others suffer is complex and multifaceted. Other researchers have shown that having positive experiences throughout childhood and having adults around who are caring helps to buffer children from the negative impacts of abuse. We will make more sense of this next week – when we will see that adaptation of our inner biology plays a key part in the story of how these experiences ripple down through the years.
If anybody needs support or help with any of the issues raised here, please do inform your GP or local mental health support providers.
BY NIALL SHERRY SPORTS EDITOR



UPMC Nowlan
Referee: David Hughes
Thomastown defied the odds to comprehensively dethrone O’Loughlin Gaels and claim their first senior county title in 78 years in testing conditions at a damp and breezy UPMC Nowlan Park. An 11-point victory certainly didn’t flatter the boys in blue as they tore into Brian Hogan’s outfit from the first whistle and were always ahead and in truth, never looked in any danger as they secured back-to-back titles at different grades on Noreside. Last weekend’s success all the sweeter, as Manager Doherty was watching from on high, due to his on going sideline suspension.
The Loughs made one late change with Conor Kelly coming in for Luke Hogan, while Paul Barron was between the sticks for the ‘Town after Diarmuid Galway failed to recover from injury.
Fittingly, it would be AllStar nominee John Donnelly that opened the scoring in the decider in the first minute, setting down a marker that Noel Doherty’s charges weren’t going to be overawed by the reigning county champions. The current All-Ireland Intermediate champions added to their opener with a fine score from the evergreen and hard-working John-Joe Farrell, who at 36 years of age demonstrated his importance to this Thomastown side. There were battles aplenty across UPMC Nowlan Park with players from both sides getting to know each other. Thomastown were standing up to their opponents, Paddy Deegan knew early on that his side were in for a battle, taking a couple of big hits, and feeling them too as he tried to mark county teammate, John Donnelly.
Fionán Mackessy was being shackled and hounded by Brian Staunton, and not being given the freedom that he perhaps had in previous rounds of this campaign. Brian
Thomastown Players Celebrate


Hogan’s outfit got off the mark, thanks to a lovely point from Owen Wall. Town midfielder Peter McDonald then created a goal opportunity for himself, cutting in along the endline before shooting across the front of goal, no doubt a let off for O’Loughlin’s. Rory Connellan then got on the scoreboard striking over a great effort to edge his side two points ahead. The game was flowing, thanks to referee David Hughes, who in his first senior final was adding much to the game. The hugely influential
John Donnelly then took advantage from a poor restart by Loughs netminder Stephen Murphy to notch his second score of the decider after 14 minutes of action at a damp and breezy UPMC Nowlan Park. John then turned provider, setting up Stephen Donnelly for a cracking point. Back from suspension, Lough captain, Mark Bergin got his team’s second score of the final after 18 minutes and the holders built on this with a classy point from Conor Heary, who sold his man a dummy before splitting the posts from
distance.
Having conceded two on the trot, Thomastown hit back with a brace of their own, John Donnelly with his 3rd of the day and a placed ball from Robbie Donnelly. The O’Loughlin’s management team made a change and switched Mikey Butler onto the all-action all-scoring, John Donnelly to see if the tigerish corner back could restrict JD’s influence on the final. Stephen Donnelly then got his name noted by referee David Hughes for a robust challenge on Huw Lawlor.

Four points down, the Loughs went in search of a score and got one from play from captain Mark Bergin, after a lovely ball from Paddy Deegan to Owen Wall, who gave the pass to his skipper. The next score was a great one, and a Thomastown one. Robbie gave a nice pass to John Donnelly who raced clear. Despite the efforts of three opposition players, John shortened his grip and struck a classy wonderful point. Another marauding run from JD saw Fionán Mackessy foul the Town man and Robbie did the needful from the
resulting free, to leave the scoreboard in UPMC Nowlan Park reading Thomastown 0-9, O’Loughlin Gaels 0-4.
Brian Hogan would have worried at his side’s showing in the opening period, having watched them be second to nearly every ball and being outfought and outmuscled. His players would have known that a fast start to the second half was vital as they sought to reel in the Thomastown lead, but their opponents weren’t about to rest on their laurels. Just two minutes into
the half, John Donnelly played in Robbie and the latter split the posts. A couple of minutes later, another Donnelly, this time, Stephen rifled over a fantastic score to extend the ‘Towns lead to seven points. The first change of the game came, the experienced Paddy Butler replacing Jack Nolan. Fionán Mackessy’s shadow, Brian Staunton then saw his name go into the referee’s book, but this didn’t deter the defender from his job. Young Colm Treacy then set up midfielder Peter McDonald for another great team score as the Thomastown faithful amongst the crowd of almost 9,500 dared to dream that their side was on the verge of delivering a first senior title since 1946. The

next piece of action encapsulated Noel Doherty’s team. Zach Bay Hammond, who had been handed the task of looking after the perpetual motion figure of Conor Heary, put in a serious shoulder on his counterpart. Totally legal, totally committed, totally Thomastown. Another change of personnel for O’Loughlin’s, the pacy Sammy Johnston entering the fray, replacing one of the many misfiring members of the attacking unit, Sean Bolger. Then came a big moment in the game. Loughs netminder Stephen Murphy pulled off an incredible save to dent Colm Treacy a certain goal from point bank range. Could this be the moment to shake the holders into action? With conditions worsening, semi-final POTM, Jamie Ryan stroked over a nice point, having been set up by Johnston. The underdogs, but now, certain favorites responded with a brace of placed balls from Robbie Donnelly. With the clock hitting 50 minutes, Owen Wall notched his second of the game, before Huw Lawlor intervened to prevent a green flag being raised at the other end when he denied Rory Connellan, but again Thomastown hit back, Robbie hitting a sweet score from play. Loughs captain Mark Bergin got his second from play shortly after, but you sensed major scores would be needed to get the current champions back in the game, but this was to be Brian Hogan’s sides last score of the county final.
A huge roar echoed around UPMC Nowlan Park when the announcer introduced Thomas ‘Tucker’
O’Hanrahan to the field of play in place of young Colm Treacy. The next score was lovely, John Joe Farrell won the ball and gave a neat pass to top scorer Robbie Donnelly who fired over. Thomastown nine ahead with five minutes of normal time remaining. The final two scores came from another brace of frees from the deadly Robbie. Three minutes of additional time were signaled, but that’s how the game finished. Thomastown, Kilkenny senior county champions 2024, on a scoreline of 0-18 to 0-7.
Scorers: Thomastown: R. Donnelly (0-8, 6 frees); J. Donnelly (0-4); S. Donnelly, J.J. Farrell (0-2 each); R. Connellan, P. McDonald (0-1 each). Scorers: O’Loughlin Gaels: M. Bergin (0-3, 1 free); O. Wall (0-2); C. Heary, J. Ryan (0-1 each).
THOMASTOWN: P. Barron; P. Connellan, J. Burke (c), N. Kirwan; Z. Bay Hammond, E. Donnelly, B. Staunton; P. McDonald, J.J. Farrell; R. Donnelly, J. Donnelly, L. Connellan; S. Donnelly, C. Treacy, R. Connellan. Subs for Thomastown: T. O’Hanrahan for C. Treacy (54); D. Prendergast for P. Connellan (58); J. Holden for S. Donnelly (60+4). O’LOUGHLIN GAELS: S. Murphy; T. Forristal, H. Lawlor, M. Butler; D. Fogarty, P. Deegan, J. Molloy; J. Ryan, J. Nolan; F. Mackessy, M. Bergin (c), C. Kelly; S. Bolger, C. Heary, O. Wall. Subs for O’Loughlin Gaels: P. Butler for J. Nolan (35); S. Johnston for S. Bolger (40); R. Buckley for C. Kelly (52).
Referee: D. Hughes (Barrow Rangers).

I, Stewart O’ Donovan intend to apply to Kilkenny County Council for Retention Planning Permission to retain existing dwelling house and the installation of a new septic tank and percolation area and all associated site development works at Geraldine, Mallardstown Upper, Callan, Co. Kilkenny, R95 PHH3.
The planning application may be inspected, or purchased at a fee not exceeding the reasonable cost of making a copy, at the offices of the Planning Department, Kilkenny County Council, County Hall, John Street, Kilkenny, during its public opening hours 9 a.m.- 1.00 p.m. and 2.00 p.m. – 4.00 p.m. Monday to Friday, and a submission or observation in relation to the application may be made to the Planning Authority in writing on payment of the prescribed fee (€20.00) within the period of 5 weeks beginning on the date of receipt by the Authority of the planning application, and such submissions or observations will be considered by the Planning Authority in making a decision on the application. The Planning Authority may grant permission subject to or without conditions, or may refuse to grant permission.
I, Cliodhna Foskin intend to apply to Kilkenny County Council for Planning permission for a part single storey dwelling & part storey and a half style dwelling, vehicular entrance, borewell, detached garage, foul treatment tank & percolation area and all associated site works at Deerpark, Mullinavat, Co. Kilkenny.
The planning application may be inspected, or purchased at a fee not exceeding the reasonable cost of making a copy, at the offices of the Planning Department, Kilkenny County Council, County Hall, John Street, Kilkenny, during its public opening hours 9.00 a.m. - 1.00 p.m. and 2.00 p.m. - 4.00 p.m. Monday to Friday, and a submission or observation in relation to the application may be made to the Planning Authority in writing on payment of the prescribed fee (€20.00) within the period of 5 weeks beginning on the date of receipt by the Authority of the planning application. The Planning Authority may grant permission subject to or without conditions, or may refuse to grant permission. Signed: Nextgen Design & Build Ltd. www.ngdb.ie
KILKENNY COUNTY COUNCIL
We, Noel Lynch and Gail Jennings intend to apply to Kilkenny County Council for full planning permission to erect an uncovered slatted slurry storage tank and ancillary concrete works on our lands at Attateenoe Upper, Callan, Co. Kilkenny. The planning application may be inspected or purchased at a fee not exceeding the reasonable cost of making a copy at the offices of the Planning Department, Kilkenny County Council, County Hall, Johns Street, Kilkenny during its public opening hours 9am-1pm and 2pm-4pm Monday to Friday. A submission or observation in relation to the application may be made to the Planning Authority in writing on payment of the fee prescribed fee (€20.00) within the period of 5 weeks beginning on the date of receipt by the Authority of the application, and such submissions or observations will be considered by the Planning Authority in making a decision on the application. The Planning Authority may grant permission subject to or without conditions, or may refuse to grant permission.
Signed: Noel Lynch and Gail Jennings.
KILKENNY COUNTY COUNCIL
I, Laura and Tim Murphy intend to apply for planning permission for development at this site situated at Annesville, Ballyda, Danesfort, Co. Kilkenny, R95 AV27
1. Demolition of existing single storey semi -detached rear extension
2. Construction of new part 2 storey and single-storey extension to the rear of the existing dwelling,
3. Reorganisation of existing internal layout of existing dwelling and adjoining family flat.
4. Replacement effluent treatment system and percolation area.
5. All associated elevational modifications,
6. All associated site developments works.
The planning application may be inspected, or purchased at a fee not exceeding the reasonable cost of making a copy, at the offices of the Planning Department, Kilkenny County Council, County Hall, John Street, Kilkenny, during its public opening hours 9 a.m.- 1.00 p.m. and 2.00 p.m. – 4.00 p.m. Monday to Friday, and a submission or observation in relation to the application may be made to the Planning Authority in writing on payment of the prescribed fee (€20.00) within the period of 5 weeks beginning on the date of receipt by the Authority of the planning application, and such submissions or observations will be considered by the Planning Authority in making a decision on the application. The Planning Authority may grant permission subject to or without conditions, or may refuse to grant permission. Signed: Gittens Murray Architects Ltd., No. 5 William Street, Kilkenny. Tel No: 056-7753933. web:www.gmarch.net

Planning Permission is sought by Jack Lennon for development at ‘Site No.1 of 4’, Dungarvan, Co. Kilkenny. The development will consist of the construction of a four-bedroom part single, part two-storey dwelling including rooflights and a detached single-storey domestic garage. Other works as part of the development include; on-site wastewater treatment system and percolation area; soakaway; vehicular entrance; landscaping; boundary treatment; borehole well; and all associated works to facilitate the development. This application is part of a development proposal comprising a total of four units across the landholding.
The planning application may be inspected, or purchased at a fee not exceeding the reasonable cost of making a copy, at the offices of the Planning Department, Kilkenny County Council, County Hall, John Street, Kilkenny, during its public opening hours 9 a.m.- 1.00 p.m. and 2.00 p.m. – 4.00 p.m. Monday to Friday, and a submission or observation in relation to the application may be made to the Planning Authority in writing on payment of the prescribed fee (€20.00) within the period of 5 weeks beginning on the date of receipt by the Authority of the planning application, and such submissions or observations will be considered by the Planning Authority in making a decision on the application. The Planning Authority may grant permission subject to or without conditions, or may refuse to grant permission.
Signed: Gittens Murray Architects Ltd., No. 5 William Street, Kilkenny. Tel No: 056-7753933.
Web: www.gmarch.net.
Planning Permission is sought by Jack Lennon for development at ‘Site No.2 of 4’, Dungarvan, Co. Kilkenny. The development will consist of the construction of a four-bedroom part single, part two-storey dwelling including rooflights and a detached single-storey domestic garage. Other works as part of the development include; on-site wastewater treatment system and percolation area; soakaway; vehicular entrance; landscaping; boundary treatment; borehole well; and all associated works to facilitate the development. This application is part of a development proposal comprising a total of four units across the landholding.
The planning application may be inspected, or purchased at a fee not exceeding the reasonable cost of making a copy, at the offices of the Planning Department, Kilkenny County Council, County Hall, John Street, Kilkenny, during its public opening hours 9 a.m.- 1.00 p.m. and 2.00 p.m. – 4.00 p.m. Monday to Friday, and a submission or observation in relation to the application may be made to the Planning Authority in writing on payment of the prescribed fee (€20.00) within the period of 5 weeks beginning on the date of receipt by the Authority of the planning application, and such submissions or observations will be considered by the Planning Authority in making a decision on the application. The Planning Authority may grant permission subject to or without conditions, or may refuse to grant permission.
Signed: Gittens Murray Architects Ltd., No. 5 William Street, Kilkenny. Tel No: 056-7753933.
Web: www.gmarch.net.
Planning Permission is sought by Jack Lennon for development at ‘Site No.3 of 4’, Dungarvan, Co. Kilkenny. The development will consist of the construction of a four-bedroom part single, part two-storey dwelling including rooflights and a detached single-storey domestic garage. Other works as part of the development include; on-site wastewater treatment system and percolation area; soakaway; vehicular entrance; landscaping; boundary treatment; borehole well; and all associated works to facilitate the development. This application is part of a development proposal comprising a total of four units across the landholding.
The planning application may be inspected, or purchased at a fee not exceeding the reasonable cost of making a copy, at the offices of the Planning Department, Kilkenny County Council, County Hall, John Street, Kilkenny, during its public opening hours 9 a.m.- 1.00 p.m. and 2.00 p.m. – 4.00 p.m. Monday to Friday, and a submission or observation in relation to the application may be made to the Planning Authority in writing on payment of the prescribed fee (€20.00) within the period of 5 weeks beginning on the date of receipt by the Authority of the planning application, and such submissions or observations will be considered by the Planning Authority in making a decision on the application. The Planning Authority may grant permission subject to or without conditions, or may refuse to grant permission.
Signed: Gittens Murray Architects Ltd., No. 5 William Street, Kilkenny.
Tel No: 056-7753933.
Web: www.gmarch.net.
Planning Permission is sought by Jack Lennon for development at ‘Site No.4 of 4’, Dungarvan, Co. Kilkenny. The development will consist of the construction of a four-bedroom part single, part two-storey dwelling including rooflights and a detached single-storey domestic garage. Other works as part of the development include; on-site wastewater treatment system and percolation area; soakaway; vehicular entrance; landscaping; boundary treatment; borehole well; and all associated works to facilitate the development. This application is part of a development proposal comprising a total of four units across the landholding.
The planning application may be inspected, or purchased at a fee not exceeding the reasonable cost of making a copy, at the offices of the Planning Department, Kilkenny County Council, County Hall, John Street, Kilkenny, during its public opening hours 9 a.m.- 1.00 p.m. and 2.00 p.m. – 4.00 p.m. Monday to Friday, and a submission or observation in relation to the application may be made to the Planning Authority in writing on payment of the prescribed fee (€20.00) within the period of 5 weeks beginning on the date of receipt by the Authority of the planning application, and such submissions or observations will be considered by the Planning Authority in making a decision on the application. The Planning Authority may grant permission subject to or without conditions, or may refuse to grant permission.
Signed: Gittens Murray Architects Ltd., No. 5 William Street, Kilkenny.
Tel No: 056-7753933.
Web: www.gmarch.net.



The Miracle Prayer
Dear heart of Jesus, in the past I have asked many favours.
This time I ask you this special one (mention favour).
Take it dear heart of Jesus and place it within your heart where your father sees it. Then in his merciful eyes it will become your own favour not mine. Amen.
Say this prayer three times for three days and your favour will be granted. Never been known to fail.
Must promise publication of prayer. M.M.

A Prayer to the Blessed Virgin
(never known to fail).
O most beautiful flower of Mount Carmel, Fruitful vine, Splendour of Heaven, Blessed Mother of the Son of God, O Star of the sea, help me and show me herein you are my Mother. O Holy Mary Mother of God, Queen of Heaven and Earth, I
beseech you from the bottom of my heart to grant my request. (Please state request). There are none that can withstand your power. O show me herein you are my Mother. I place this cause in your hands (three times). Thank you for your mercy towards me and mine. Amen.
This prayer must be said for three days and after this the request will be granted. This prayer must be published immediately. P.K.

The Miracle Prayer
Dear heart of Jesus, in the past I have asked many favours.
This time I ask you this special one (mention favour).
Take it dear heart of Jesus and place it within your heart where your father sees it. Then in his merciful eyes it will become your own favour not mine. Amen.
Say this prayer three times for three days and your favour will be granted. Never been known to fail.
Must promise publication of prayer. M.M.

The Miracle Prayer
Dear heart of Jesus, in the past I have asked many favours.
This time I ask you this special one (mention favour).
Take it dear heart of Jesus and place it within your heart where your father sees it. Then in his merciful eyes it will become your own favour not mine. Amen.
Say this prayer three times for three days and your favour will be granted.
Never been known to fail.
Must promise publication of prayer. A.B.

Dear heart of Jesus, in the past I have asked many favours. This time I ask you this special one (mention favour).
Take it dear heart of Jesus and place it within your heart where your father sees it. Then in his merciful eyes it will become your own favour not mine. Amen.
Say this prayer three times for three days and your favour will be granted.
Never been known to fail.
Must promise publication of prayer. M.B.

There are none that can withstand your power. O show me herein you are my Mother. I place this cause in your hands (three times). Thank you for your mercy towards me and mine. Amen.
This prayer must be said for three days and after this the request will be granted. This prayer must be published immediately. S.M.

The Miracle Prayer
Dear heart of Jesus, in the past I have asked many favours.
This time I ask you this special one (mention favour).
Take it dear heart of Jesus and place it within your heart where your father sees it. Then in his merciful eyes it will become your own favour not mine. Amen.
Say this prayer three times for three days and your favour will be granted. Never been known to fail.
Must promise publication of prayer. P.K.

The Miracle Prayer
Dear heart of Jesus, in the past I have asked many favours.
This time I ask you this special one (mention favour).
Take it dear heart of Jesus and place it within your heart where your father sees it. Then in his merciful eyes it will become your own favour not mine. Amen.
Say this prayer three times for three days and your favour will be granted.
Never been known to fail.
Must promise publication of prayer. J.M.

























